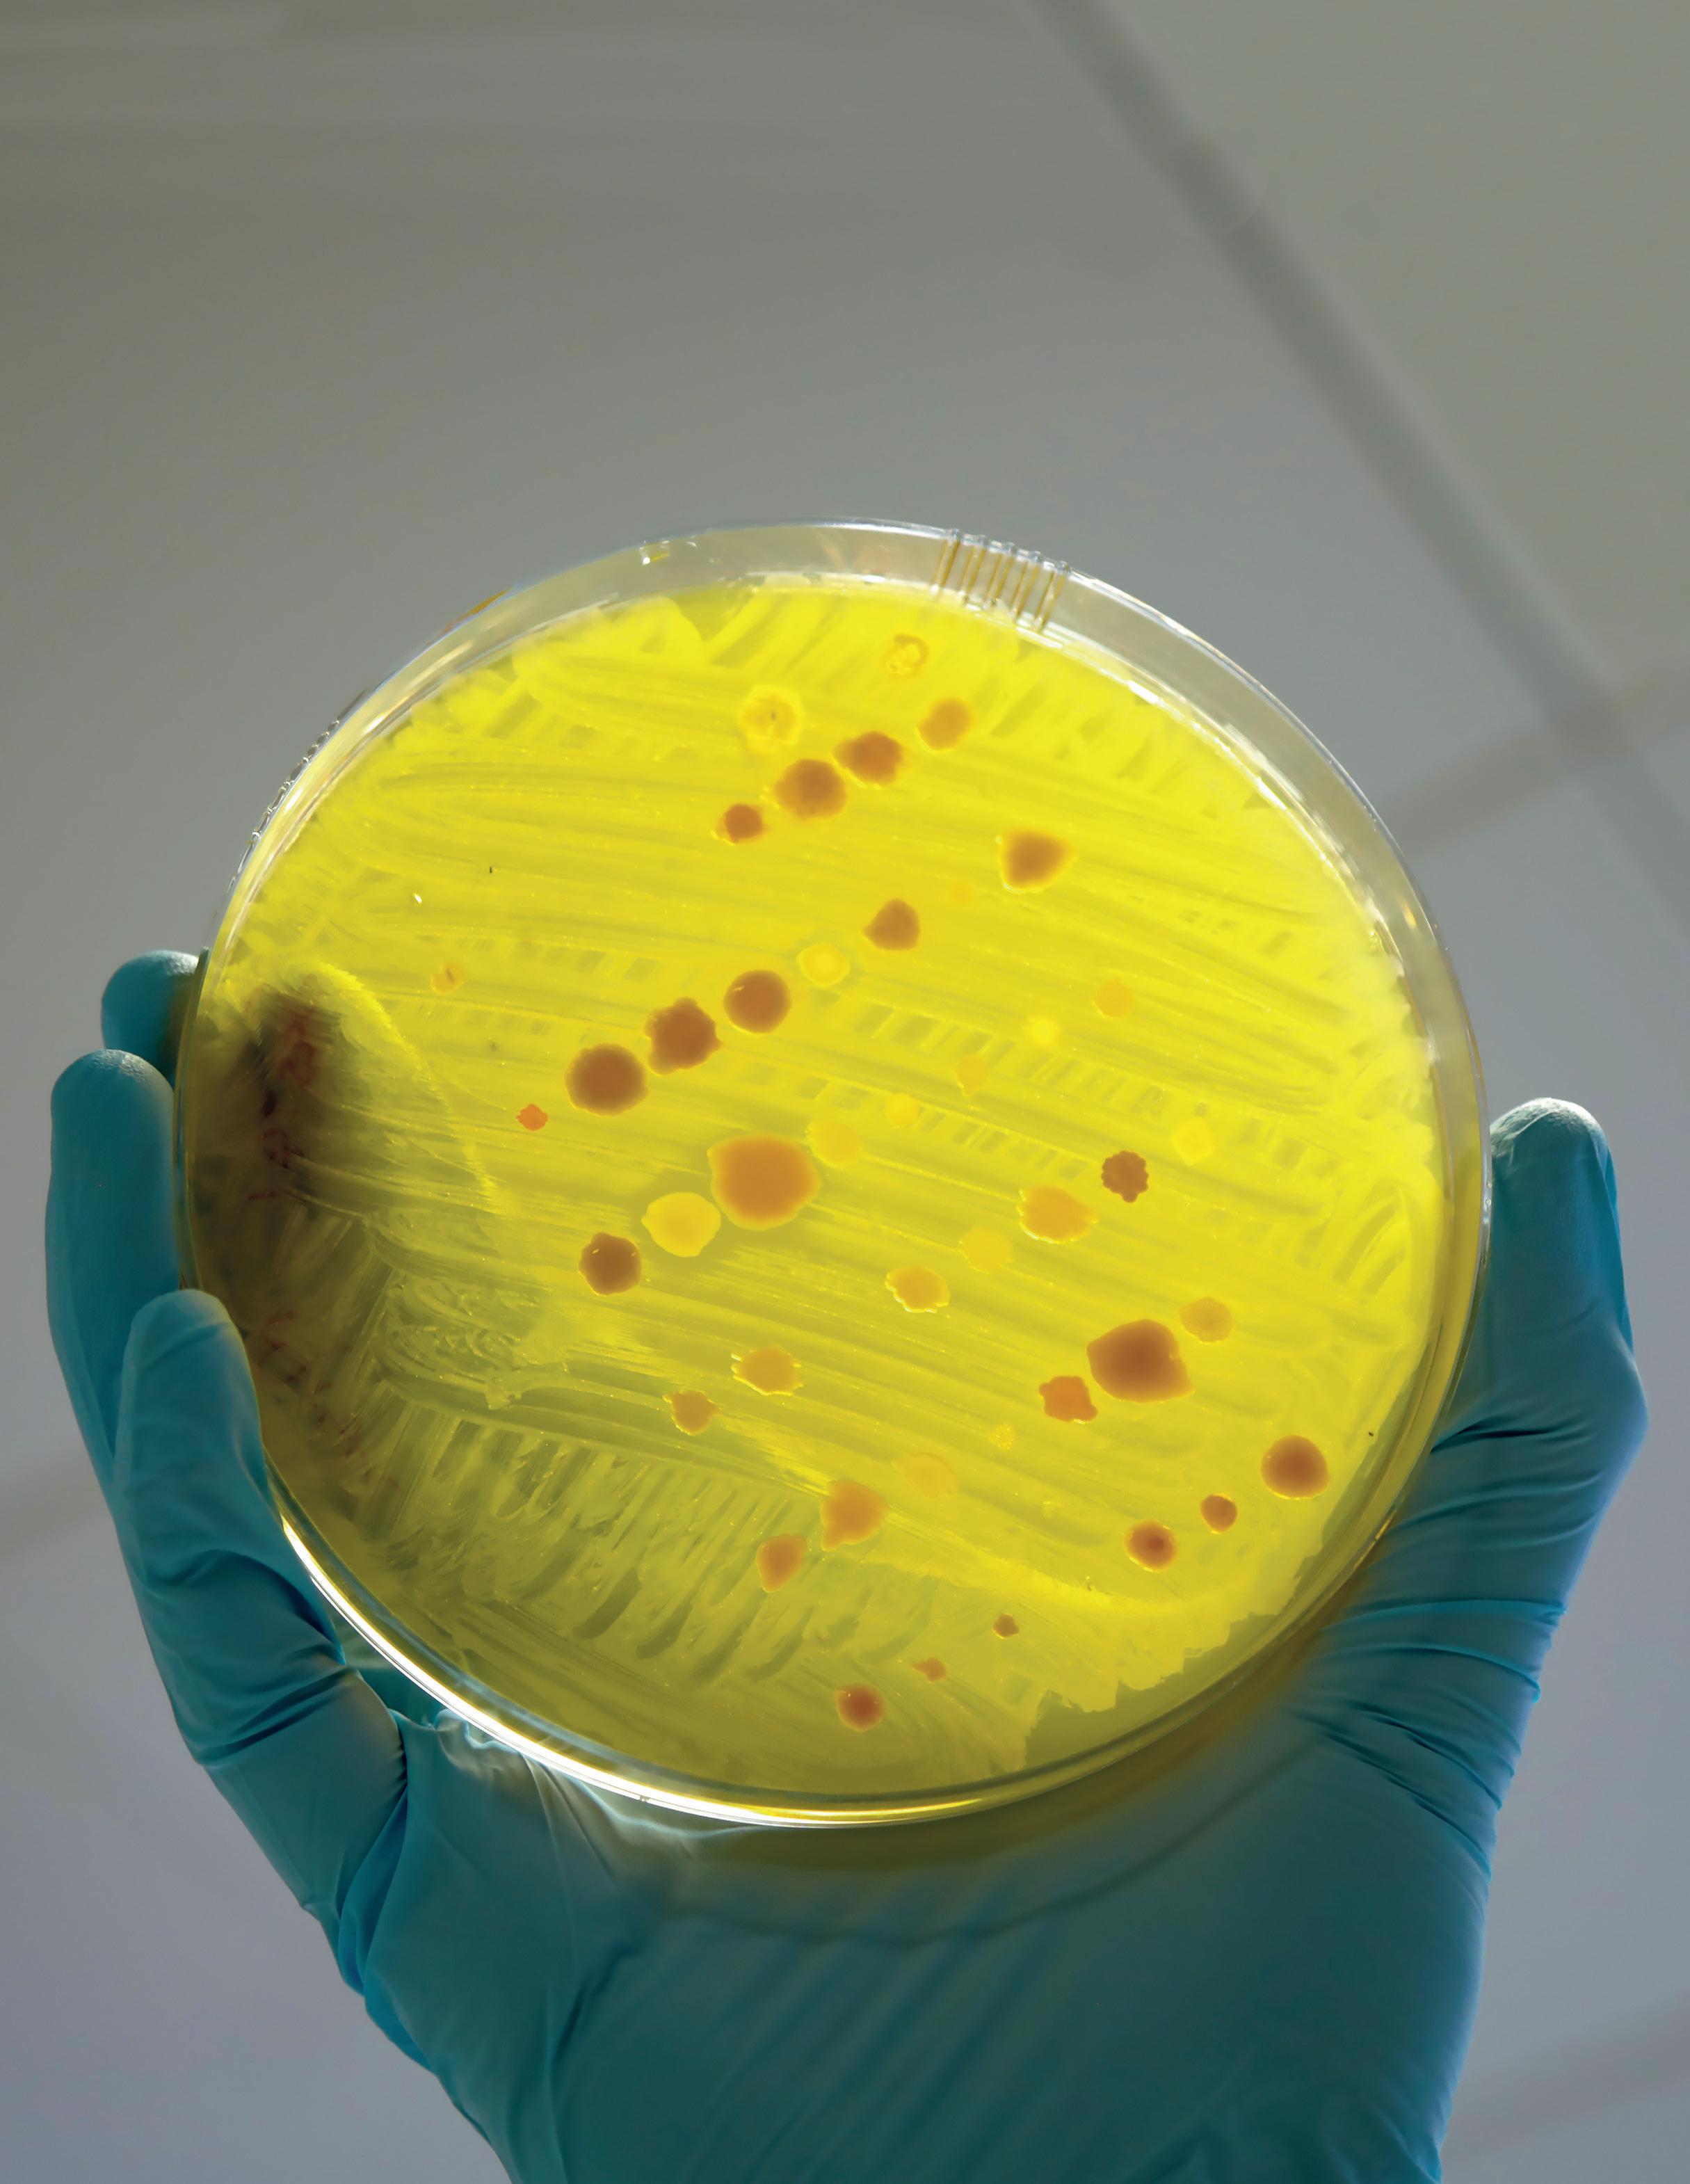

Miraklet som skapat ett monster


kungl. skogs- och lantbruksakademiens tidskrift Nummer 5 • 2022 Årgång 161
Antibiotikaresistens/AMR med fokus på djur
Ansvarig utgivare Eva Pettersson, akademiens sekreterare och vd, KSLA Redaktionsgrupp Marianne Elvander, Per Eriksson, Maria Lundesjö, Jimmy Lyhagen, Annika Åhnberg Omslagsbild En mängd olika bakterier – testning av antimikrobiell resistens. Foto: DFID – UK Department for International Development, CC BY 2.0.
Grafisk form Ylva Nordin, KSLA
Tryckeri Gävle Offset, Gävle Tryckår/månad 2022/11
Upplaga 1300 ex ISSN 0023-5350
ISBN 978-91-88567-71-0 (tryck), 978-91-88567-72-7 (pdf)
Samtliga av de senaste årens utgivna nummer finns tillgängliga som nedladdningsbara filer på akademiens hemsida www.ksla.se.
Miraklet som skapat ett monster
Antibiotikaresistens/AMR med fokus på djur
Kungl. Skogs- och Lantbruksakademiens TIDSKRIFT
4
nr 5 2022
Innehåll
Förord 7
Arbetet mot antibiotikaresistens och AMR måste intensifieras 8
Vad innebär antibiotikaresistens? 10
EN PLATTFORM FÖR NYA PERSPEKTIV
Antibiotikakriterierna – ett praktiskt verktyg 12
Det går att göra skillnad – ett företagsperspektiv 15
Antibiotikafria livsmedel – kan det vara annat än bra? 17
Antibiotikaresistens – ett hot mot folkhälsan som kan hanteras om viljan finns 19
Antibiotikaanvändning i växtodlingen 22
GLOBAL UTBLICK
Stora risker när intressen krockar 26
Antibiotikaresistens och antibiotikaanvändning i ett globalt perspektiv 32
Antimicrobial use in low-income countries – with examples from Uganda 36
Förbättrad EU-lagstiftning – kommer den att fungera? 40
FÖREGÅNGSLANDET SVERIGE
Så blev Sverige ett föregångsland 43
Så arbetar vi idag i Sverige mot antibiotikaresistens i grisuppfödningen 46
Samverkan och statligt ansvar – framgångsfaktorer bakom Sveriges låga bruk av antibiotika i animalieproduktionen 52
Avslutande reflexioner 56
Ordlista och akronymer 58
Författarpresentationer 60
Miraklet som skapat ett monster – antibiotikaresistens/AMR med fokus på djur
5
Kungl. Skogs- och Lantbruksakademiens TIDSKRIFT
6
nr 5 2022
Förord
Antimikrobiell resistens (AMR) utgör ett växande globalt hot och KSLA har sedan länge ett starkt engagemang i frågan. Globalt relaterar den övervägande delen av antibiotikaanvändningen till djurhållningen då det inte enbart används som läkemedel utan på många håll även som tillväxtbefrämjare. I Sverige har vi dock kommit långt eftersom endast ca 13 procent av all antibiotika används i djurhållningen och då enbart som läkemedel. Sverige har arbetat länge med detta – ända sedan 1980-talet – och är nu en förebild.
Akademien är en oberoende plattform för aktörer från olika delar av samhället för möten kring olika frågor med koppling till de areella näringarna och som har stor betydelse för samhället i stort. AMR är definitivt ett område som passar in i akademiens verksamhet.
Vi har genom årens lopp genomfört många aktiviteter på temat AMR och det var vid ett seminarium 2019 som tanken på en närmare samverkan mellan KSLA och Axfoundation föddes. Det resulterade senare i Antibiotikaplattformen – från gård till gaffel. Plattformens arbete följer i huvudsak två spår: kunskapsupp byggnad och dialog om antibiotika.
Således har ett flertal seminarier genomförts på KSLA med syftet att belysa frågan och därmed höja kun skapen inom området. Som exempel kan nämnas seminariet om hur handelspolitiken kopplas till AMR. Det pågår mycket inom detta område och bland annat har en ny veterinär läkemedelsförordning trätt i kraft i år inom EU, som ställer krav även på djurproduktionen utanför EU. Ett annat seminarium har belyst finansmarknaden och möjligheterna att investera i ansvarstagande företag eller att upphöra att investera i företag med verksamhet relaterad till felaktig användning av antibiotika inom djurhållning. De seminarier som genomförts går det att ta del av på KSLA:s hemsida.
Den andra delen av plattformen är antibiotikadialogen som syftar till en ökad dialog mellan marknadsaktörer inom exempelvis dagligvaruhandel och livsmedelsindustri. Frågor som har diskuterats är vilka krav som kan ställas på leverantörer inom livsmedelshandel och industri och hur kraven kan följas upp. Dialogen bygger i hög grad på de antibiotikakriterier som Axfoundation tagit fram tidigare. Därutöver är plattformen en mötesplats och ett nätverk för andra aktörer som är verksamma i arbetet för låg och ansvarsfull antibiotikaanvändning.
Arbetet mot den ökande resistensen måste fortsätta och KSLA kommer att fortsätta att vara engagerad, i synnerhet i den del av arbetet som rör djurhållningen och i fortsatt samverkan med andra aktörer.
Detta nummer av KSLAT är en del i det viktiga byggandet av kunskap om området antibiotikaresistens och AMR.
Eva Pettersson Akademiens sekreterare
Miraklet som skapat ett monster – antibiotikaresistens/AMR med fokus på djur
7
Arbetet mot antibiotikaresistens och AMR måste intensifieras
Annika Åhnberg
Utan tvekan har antibiotika varit ett mirakel för mänskligheten. Tidigare livshotande sjukdomar orsakade av bakterier, som tuberkulos och lungin flammation, kan vi nu bota. Svåra infektioner i sår kan hävas. Inom cancervård, vid stora operationer och för vård av för tidigt födda barn, gör antibiotika en ovärderlig nytta. Miljontals människors liv har sparats under de dryga sjuttio år, som antibiotika varit tillgänglig.
Även för husdjur – sällskapsdjur och produk tionsdjur – blev antibiotika snabbt ett mirakelme del för att bota sjukdom och skador, precis som för människor. Användningsområdet för antibiotika substanser växte gradvis och snart blev det också uppenbart att tillsatser av antibiotika kunde åstad komma underverk även inom animalieproduktio nen. Med antibiotika i låga doser inblandat i fodret växte djur fortare och höll sig friska trots bristfälliga miljöer. Livsmedelsproduktionen kunde intensifie ras, maten blev billigare.
Visst låter det här för bra för att vara sant? Och när något verkar för bra för att vara sant då bru kar det inte heller vara sant. Det gäller även här. I skuggan av alla fördelarna växte också ett monster. Det monstret heter antibiotikaresistens. För den som är sjuk eller skadad innebär antibiotikaresistens att medicinen inte längre fungerar. Lågt räknat dör idag fler än 700 000 människor per år på grund av att antibiotikan de får inte längre fungerar. Lågt räknat kommer antalet dödsfall per år att vara 10 miljoner år 2050. Det kan jämföras med att det totala antalet döda i covid-19, som enligt WHO i april 2022 var 6,2 miljoner.
Den tysta pandemin
Antibiotikaresistens kallas ibland för den tysta pan demin. Den pandemi som världen nyss drabbades av – och fortfarande lever med – covid-19, har överallt
stått högst på agendan hos politiker, myndigheter, näringsliv, media och medborgare. Men antibiotikaresistensen, som snart kommer att skörda fler liv per år, möter inte motsvarande engagemang. Medan kampen mot covid-19 präglats av samverkan över nations- och andra gränser, massiva informations insatser, enorma investeringar i forskning och ut veckling samt hög medvetenhet hos medborgarna så kännetecknas i stället kampen mot antibiotikaresistens av splittrade aktioner, motstridiga intres sen, brist på information, lågt intresse från media och bristande kunskaper hos medborgare.
Idag ges 70 procent av all antibiotika till djur. Globalt används mer antibiotika till friska djur än till sjuka människor; det ska dock tilläggas att det inom EU är förbjudet att använda antibiotika i tillväxtbe främjande syfte. Med en ökande befolkning i värl den växer efterfrågan på livsmedel. Konsumtionen av kött och mejeriprodukter förväntas öka. Därför kommer också produktionen att öka, och därmed risken för ökad användning av tillväxtbefrämjande antibiotika till livsmedelsproducerande djur. Ökad användning leder dessvärre till ökad risk för antibio tikaresistens hos fler och fler bakterier. Stora föränd ringar måste ske inom världens animalieproduktion om detta hot ska kunna avvärjas. I det avseendet är Sverige en förebild – som första land i världen lagstiftade vi 1986 om ett förbud mot användning av antibiotika i tillväxtbefrämjande syfte.
Det vi vill uppnå både för människor och djur är inte ett stopp för antibiotikaanvändning, men ett stopp för onödig antibiotikaanvändning. För att sjuka människor och sjuka djur ska kunna botas med antibiotika även i framtiden måste den felaktiga an vändningen upphöra.
All användning av antibiotika bidrar till utveck lingen av resistens hos bakterier. Den kunskapen har funnits i princip lika länge som antibiotika har funnits. Just därför borde en slentrianmässig och
Kungl. Skogs- och Lantbruksakademiens TIDSKRIFT nr 5 2022
8
storskalig användning ha kunnat undvikas. Men insikten om resistensmekanismer förträngdes och mer kortsiktiga lönsamhetskrav kom att driva ut vecklingen.
Bakterier är levande organismer. De kommer att fortsätta dela med sig av gener till andra bakterier och därmed också kunna överföra resistens. De bak terier som är resistenta kommer att överleva och för öka sig genom delning. Men ju mindre antibiotika vi använder desto långsammare går den utvecklingen. Samtidigt måste forskning och utveckling för att få fram nya läkemedel inom human- och veterinärmedicin ständigt fortgå.
God djuromsorg minskar behovet av antibiotika
En välgrundad svensk kunskap är att den bästa me toden för att minska användningen av antibiotika inom djurhållningen är att förebygga sjuklighet genom god djuromsorg. Ändamålsenliga och rena djurstallar, tillräckligt med utrymme, möjlighet att utöva naturliga beteenden och bra foder är exempel på faktorer som skapar en bra livsmiljö.
Idag ligger tyngdpunkten i arbetet mot antibio tikaresistens på humansidan. Vi ser goda resultat av det i Sverige. Läkare skriver inte längre slent rianmässigt ut antibiotika och patienter tjatar inte. Utvecklingen är dock ojämnt fördelad över landet och i skrivande stund (hösten 2022) rapporteras att användningen åter ökar i delar av Sverige. På många håll i världen är det fortfarande alldeles för enkelt att använda mirakelmedicinen antibiotika i alla möjliga och omöjliga sammanhang och därmed göds också monstret. Kampen för en minskad och ansvarsfull användning av antibiotika måste intensifieras och arbetet inom humanvården måste gå hand i hand med arbetet på djursidan. Begreppet ”One Health” innebär att biologer, läkare, veterinärer och ekologer, men också samhällsvetare, ekonomer och politiker samarbetar för att säkra hälsan för människor, djur och natur. Inom ramen för detta ”gemensam hälsaperspektiv” måste fokus på djursidan bli starkare.
Under 2022 överlämnade generaldirektören för SVA, Ann Lindberg, sin utredning Friska djur be höver inte antibiotika – bättre verkan genom inter nationell påverkan (SOU 2022:43) till regeringen. Utredningen lämnar förslag på åtgärder som den svenska regeringen bör genomföra för att effekti visera och utveckla arbetet för att få till stånd en ansvarsfull och minskad antibiotikaanvändning i djurhållningen globalt. Under 2022 utsåg regeringen också Malin Grape, tidigare chef för Folkhälsomyndighetens enhet för antibiotika och vård hygien, till AMR-ambassadör med uppgift att stär ka Sveriges roll internationellt.
Nödvändigheten av ökat fokus på djursidan och insikten om att en god djurhälsa är grunden för minskad användning av antibiotika till djur var ut gångspunkter när ”Antibiotikaplattformen – från gård till gaffel” startades gemensamt av KSLA och Axfoundation 2020. De insikterna är också grun den för detta nummer av KSLAT. Det vi vill med plattformen och med tidskriften är dels att upp märksamma nya områden där arbetet måste inten sifieras, dels att visa på nya arbetssätt som medger att drivkraften att minska antibiotikaanvändningen finns inom samhällets alla områden, hos producen ter, konsumenter och inom olika förvaltningsorgan.
Artiklarna har samlats i tre block. Det första tar upp verksamheten i plattformen. Det andra gör en global utblick och belyser de stora utmaningarna på global nivå. I det sista blocket beskrivs den svenska utvecklingen. De erfarenheter som har gjorts genom åren i Sverige kan vara till god nytta i andra länder när man nu på allt fler håll inser allvaret i situatio nen och växlar upp ambitionerna. Användningen av antibiotika i djurhållningen i Sverige är den lägsta inom EU och förekomsten av resistens är mycket låg.
Vi hoppas att du som läser ska inspireras, få nya insikter och kunskaper och kanske också hitta om råden för dig att verka inom i det framtidsavgörande arbetet mot ökad antibiotikaresistens.
God läsning önskar redaktionsgruppen!
Miraklet som skapat ett monster – antibiotikaresistens/AMR med fokus på djur
9
Vad innebär antibiotikaresistens?
Marianne Elvander
Vad innebär resistens?
• För patienten betyder det att den bakterieinfektion man drabbats av inte kan botas med antibiotika;
• för bakterierna betyder det att de inte dör av en antibiotikabehandling, men även att de kan föra resistens vidare till andra bakterier.
Hur sker det?
Bakterier, som är encelliga organismer, förökar sig genom att bakteriecellen delar sig. Det sker snabbt. Vissa bakterier hinner dela sig flera gånger under en timme. Vid varje celldelning kan förändringar ske i arvsmassan (mutationer). Det gör att de nybildade bakterierna kan få nya egenskaper. De bakterier som har bäst förmåga att överleva kommer att föröka sig mest och antibiotikaresistens är en sådan egenskap.
Bakterier finns i miljontals olika varianter varav endast en liten andel är sjukdomsframkallande (pa togena). Många bakterier har en utvecklad förmåga att ta upp arvsmassa i form av DNA-segment från sin omgivning för olika ändamål där utveckling av
en viss egenskap – såsom resistens – är en. Resistens kan även uppstå genom en spontan mutation i bak teriens DNA. Mutationer är vanligt eftersom bak terier delar sig snabbt och behöver kopiera sitt DNA snabbt och lite ”slarvigt”.


Antibiotikaresistens kan på mycket kort tid spri das mellan bakterier genom att information i form av särskilda DNA-segment överförs från en bakterie till en annan. Dessa segment kan innehålla resis tensgener som skyddar bakterien mot ett eller flera antibiotika. Överföringen sker ofta i form av en plasmid, en liten cirkulär DNA-bit, som kan bära på resistensgener, och som relativt enkelt kan överföras mellan olika bakterietyper.

I närvaro av ett antibiotikum har bakterier som bär på resistens mot detta antibiotikum en fördel och växer till, medan andra bakterier, som är känsliga för den aktuella antibiotikasubstansen, dör. Därmed kommer andelen resistenta bakterier i kroppen öka snabbt vid antibiotikabehandling. Om ”rätt” anti biotikum används mot en infektion, det vill säga en substans som den sjukdomsframkallande bakterie
Kungl. Skogs- och Lantbruksakademiens TIDSKRIFT nr 5 2022
10
Icke-resistenta bakterier existerar Bakterier multipliceras miljard tals gånger Vissa mutationer gör bakterien antibiotika resistent Resistenta bak terier förökar sig och frodas I närvaron av antibiotika överlever endast de resistenta bakterierna Några av dessa baktierer muterar Mutation i DNA:t GENETISK MUTATION ORSAKAR ANTIBIOTIKARESISTENS
efter NIAID (National Institute of Allergy and Infectious Diseases) USA, Public domain.
Fritt
stammen är känslig för, kommer medicinen i sam verkan med kroppens eget immunförsvar att kunna bota infektionen.
Vad händer vid en infektion?
Många av oss bär helt ovetande på en resistent bakterie, och saknar vetskap om hur vi smittades. Kanske var det på en utlandsresa, där framför allt kontakt med sjukvården utgör en riskfaktor.
Om du bär på resistenta bakterier, antingen efter en tidigare antibiotikakur eller som en ”smitta” från andra människor, djur eller din närmiljö, kommer dessa att skapa problem när du behöver antibiotikabehandling. Ett scenario kan vara att du skär dig och dina hudbakterier hamnar i såret. Dessa förökar sig genom delning och snart är fingret inflammerat. Vid ett läkarbesök får du en antibiotikakur – men om några av bakterierna i såret är resistenta och står emot antibiotikabehandlingen så kommer de att fortsätta att dela sig och snart är samtliga bakterier i såret resistenta. Infektionen kan fortgå och förvärras
och om inte något annat mer kraftfullt antibioti kum finns att tillgå kanske fingret i slutändan måste amputeras. Är scenariot en lunginflammation är det stor risk att du dör.
Hur allvarligt är problemet? Det är mycket allvarligt. Om utvecklingen fortsätter mot att allt fler bakterier blir resistenta så kommer det inte finnas möjlighet att bota vanliga sjukdomar och människor kommer att dö av ibland ganska ba nala infektioner precis som på medeltiden. Det kom mer inte heller gå att genomföra behandlingar som innebär att immunsystemet blir kraftigt nedsatt, till exempel cancerbehandlingar och transplantationer. Enligt WHO är detta ett reellt scenario, och de gör bedömningen att år 2050 kan det bli ca 10 miljoner dödsfall globalt. Enligt en nyligen publicerad artikel i tidskriften Lancet beräknas dödligheten 2019 på grund av antibiotikaresistens globalt till 1,27 mil joner. I en annan artikel har dödligheten för enbart Europa beräknats till 500 000 samma år.
Svenska forskare testade frivilliga före och efter utlandsresor för att se om de plockade upp en ”super-bug”, känd som ESBL-bakterie (bär på enzymer som gör dem resistenta mot antibiotikagruppen beta-laktamer, en av de mest användbara antibiotikaklasserna) på sina resor.
Källa: Thomas Tangden et al. i Antimicrobial Agents and Chemotherapy, sept 2010, CC BY-SA 4.0.
Källor
Göteborgs universitet: https://www.gu.se/en/care/education-outreach-videos/the-problem-of-antibiotic-resistance-all-lectures
The Lancet: https://www.thelancet.com/journals/lancet/article/PIIS0140-6736(21)02724-0/fulltext och https://www.thelancet.com/journals/lanpub/article/PIIS2468-2667(22)00225-0/fulltext
Miraklet som skapat ett monster – antibiotikaresistens/AMR med fokus på djur

11
Afrika Asien (exklusive Indien) Centralamerika Indien Mellanöstern Nordamerika Sydamerika Södra Europa Totalt antal resande 25 31 6 8 14 2 1 16 Av åtta resande som åkte till Indien plockade sju upp bakterien
Antibiotikakriterierna – ett praktiskt verktyg
Maria Lundesjö
Vad kan vi tillsammans göra för att minska anti biotikaanvändningen till livsmedelsproducerande djur och dessutom få övriga i livsmedelsbranschen att göra detsamma? Den frågan ställde Åsa Domeij, hållbarhetschef på Axfood, när hon ringde upp Axfoundation 2013. Det blev upptakten till dagens antibiotikakriterier, som är ett handfast verktyg för livsmedelsbranschen för att kunna ställa krav och följa upp leverantörer av kött, mejeriprodukter och sjömat vad gäller antibiotikaanvändning samt djur välfärd. Hösten 2020 lanserade Axfoundation en skärpt version av antibiotikakriterierna som även inkluderar ett frågebatteri och utbildningsmaterial inom bland annat antibiotikaresistens.


Ansvar för minskad antibiotikaanvändning
Alla sektorer som använder antibiotika behöver ta ett ökat ansvar för att vända utvecklingen för antibio tikaanvändning och resistens. Eftersom den största antibiotikaanvändningen idag finns inom djur hållningen har alla aktörer inom livsmedelskedjan ett ansvar för att spridning av antibiotikaresistens hos de livsmedelsproducerande djuren minimeras. Effektiva insatser som når alla led kräver samver kan. Därför har Axfoundation tillsammans med företag, akademi, myndigheter samt bransch- och civilsamhällesorganisationer utvecklat en tydlig lista
med kriterier och tillhörande frågebatteri som bland annat inköpare kan använda i dialogen med leve rantörer av kött, mejeriprodukter och sjömat (vild fångad eller odlad fisk och skaldjur). Axfoundations förhoppning är att dessa ska bidra till en lägre an vändning av antibiotika till livsmedelsproducerande djur, bättre djurhållning och minskad utveckling av antibiotikaresistenta bakterier.

Stor möjlighet för inköpare att påverka Grossister och inköpare av varor till dagligvaruhan deln och till offentliga måltider har stor möjlighet att påverka vilka krav som ställs när inköp görs. I många fall regleras viktiga hållbarhets- och djur omsorgskrav i de övergripande avtal som köpare och leverantör sätter upp för att affären ska gå i lås. Det är däremot inte lika vanligt att det tydliggörs på vil ket sätt dessa krav ska följas upp eller utvärderas. Att ställa krav och följa upp dem kan också vara kompli cerat beroende på hur inköpskedjan ser ut. Råvaror och enklare produkter är det lättare att ställa krav på, i och med att det är färre steg i produktionskedjan än vad det är när det gäller sammansatta produkter och färdiga maträtter där många komponenter kan ingå. Att ställa krav gällande ett paket fläskkotletter är betydligt enklare än att säkerställa att en salami producerats med låg antibiotikaanvändning.
Kungl. Skogs- och Lantbruksakademiens TIDSKRIFT
12
nr 5 2022 EN PLATTFORM FÖR NYA PERSPEKTIV
Listan med kriterier har ett frågebatteri som kan användas i dialogen med leverantörer av kött, sjömat (inklusive odlad fisk) och mejeripro dukter. Syftet är minskad antibiotikaanvändning och bättre djurvälfärd. Foton: Ylva Nordin.
Exempel på en kort leverantörskedja
En inköpare av ost vill erbjuda en delikatessost i dagligvaruhandeln. Kontakt upprättas direkt med ett mejeri i ett europeiskt land. Mejeriet erbjuder en ost tillverkad på mjölk från en specifik gård där de har en god relation med lantbrukaren. Här kan de krav och specifikationer som inköparen ställer kommuniceras direkt till både mejeri och lantbrukare. Om ett förbättringsarbete behöver göras kring rutiner så är få led inblandade.
Exempel på en lång leverantörskedja
En inköpare av ost vill erbjuda en delikatessost i dagligvaruhandeln. Kontakt tas med en grossist som samarbetar med en europeisk inköpsorganisation. Inköpsorganisationen upphandlar en ost som produceras av tre olika mejerier i ett europeiskt land. Varje mejeri har drygt 100 gårdar som levererar mjölk in till produktionen. Här måste de krav och specifikationer som inköparen ställer kommuniceras genom många led och det ökar risken för att aktörer inte kommer att visa så stort engagemang i frågan. Om osten dessutom ska användas i en sammansatt produkt, exempelvis som ingrediens i en pizza, till kommer produktionsstället där pizzan tillverkas. Producenten behöver då ställa krav på alla aktörer inom sin leverantörskedja.
Krav och uppföljning går hand i hand Uppföljningen kan ske på olika sätt och med olika nivåer av kontroll inom den egna organisationen. Om det finns lagstiftning kopplad till det krav man ställer är det vanligt att som inköpare förutsätta att leverantören lever upp till gällande lagstiftning och att det därför kontrolleras av någon annan aktör som exempelvis myndigheter i landet det gäller. Det är också vanligt att de kontroller som görs är stickprov på olika nivåer i leverantörskedjan för att bedöma risken för att något inte går till som det är avta lat. Men att förlita sig på lagkrav och göra stickprov kommer inte att ta oss hela vägen fram. Genom att inköpare använder antibiotikakriterierna i dialogen med leverantörer blir det enklare att följa upp och säkerställa att rätt parametrar adresseras inom just antibiotika och djurvälfärd.

Åtta antibiotikakriterier som underlättar dialogen med leverantörer Kriterielistan består av åtta kriterier som dels berör direkt antibiotikaanvändning, dels förebyggande in satser. Till varje kriterium finns tillhörande frågor att använda för leverantörsdialog och -uppföljning.
Kriterier för minskad direkt antibiotikaanvändning
1. Antibiotika ska inte användas i tillväxtbefräm jande syfte.
2. Antibiotika ska endast användas efter ordination av veterinär och ska vara godkända för använd ning till livsmedelsproducerande djur i enlighet med Codex Alimentarius.
3. Det ska finnas utförlig dokumentation av all användning av antibiotika, inklusive via foder och vatten. Ansvarig veterinär ska regelbundet gå igenom och signera dokumentationen. Data över användningen av antibiotika bör vid förfrå gan kunna tillhandahållas av aktörerna i leveran törskedjan.
4. Om antibiotika återkommande används till alla, eller majoriteten av, djur i en viss ålderskategori ska skälen för detta dokumenteras, utredning ska genomföras av veterinär och ett åtgärdsprogram för att motverka hälsoproblemen ska tas fram och tillämpas. Målsättningen är att fasa ut åter kommande användning.
5. Användning av kolistin, fluorokinoloner samt tredje eller fjärde generationens cefalosporiner –det vill säga antibiotika som är särskilt viktiga för
Miraklet som skapat ett monster – antibiotikaresistens/AMR med fokus på djur
13 EN PLATTFORM FÖR NYA PERSPEKTIV
humansjukvården – ska endast ske när veterinär bedömer att inga andra behandlingsalternativ är effektiva.
Kriterier för förebyggande, indirekta insatser som kan leda till minskad antibiotikaanvändning
6. För ett aktivt arbete med minskad antibiotikaanvändning i såväl djurbesättningen som på anläggningen ska en plan med rutiner för före byggande hälsovård och minskad smittspridning finnas och följas. Planen ska ha fokus på stra tegiskt förebyggande djurhälsoarbete inklusive smittskydd och djurvälfärd (se de fullständiga kriterierna för vad planen ska omfatta).
7. Djur ska inte stympas för att möjliggöra en brist fällig djurhållning.
8. Djur ska hållas på ett sätt som ger dem utrymme att röra sig obehindrat och kunna vila på ett för djuren lämpligt sätt.
idé till implementerade kriterier
• Den första versionen av antibiotikakriterierna utvecklades 2013–2014 i en inkluderande process tillsammans med Axfood, Martin & Servera, samt flera experter inom området. Kriterierna testades först inom de två bo lagen för att sedan lanseras brett 2014.
• Under 2016 antog medlemmarna i Svensk Dagligvaruhandel (SvDH) gemensamt ett ställningstagande för att minska antibiotikaanvändningen i livsmedelsproduktionen. Den gemensamma branschöverenskommelsen inkluderade Axfood, Bergendahls, Coop, ICA, Lidl, IKEA Foods och Livsmedelshandlarna. Ställningstagandet byggde på de fyra första kriterierna i Axfoundations Antibiotikakriterier 1.0 och gällde enbart företagens egna varumärken.
• Under åren 2019–2020 uppdaterade Axfoundation antibiotikakriterierna för att anpassas till ny lagstiftning, förändrat konsumentbeteende och för att ta steget vidare mot en positiv utveckling inom animalisk livsmedelsproduktion. I processen samarbetade företag, akademi, myndigheter samt bransch- och civilsamhälles organisationer för att hitta gemensam mark i frågan.

• Antibiotikakriterierna 2.0 innebär en förstärkning inom fler områden. Kriterierna omfattar nu sjömat och en begränsning för antibiotika som är särskilt viktig inom humansjukvården. Frågebatteriet har också förbättrats och innehåller nu tydligare rekommendationer för uppföljning.
• År 2020 antog SvDH en ny branschöverenskommelse som bygger på de sex första kriterierna i Axfoundations Antibiotikakriterier 2.0.
• Idag arbetar Axfoundation med att sprida Antibiotikakriterierna 2.0 inom den svenska dagligvaruhandeln och foodservice, till nationella och internationella organ samt till myndigheter för att uppnå en transformativ förändring.
Antibiotikariterierna med tillhörande frågebatteri och utbildningsmaterial går att ladda ned i sin helhet på https://www.axfoundation.se/antibiotika
Kungl. Skogs- och Lantbruksakademiens TIDSKRIFT
14
5 2022 EN PLATTFORM FÖR NYA PERSPEKTIV
nr
Från
Kriterierna ska bidra till lägre användning av antibiotika till livsmedelsproducerande djur, bättre djurhållning och minskad utveckling av antibiotikaresistenta bakterier. Foto: Per Eriksson.
Det går att göra skillnad – ett företagsperspektiv
Det går att ställa krav och göra skillnad i livsmedelsproduktionen i Europa även om man är en aktör i Sverige. År 2016 fattade Coop ett beslut om att börja arbeta målinriktat och aktivt med antibio tikafrågan för att bidra till bättre djuromsorg och minska onödigt användande av antibiotika. Det som till en början kunde kännas som ett omöjligt upp drag visade sig inte alls vara så svårt när vi började ställa tydligare krav.

Coops arbete med griskött importerat från två EU-länder
Den allra största delen av köttet och charkproduk terna som säljs i våra butiker kommer från Sverige, exempelvis är cirka 90 procent av det färska köttet svenskt. Varför inte allt kött i våra butiker är svenskt har två anledningar. Dels är vi inte självförsörjan de i Sverige på kött, dels vill vi erbjuda utländska produkter såsom parmaskinka och salami som kunderna efterfrågar. När det gäller importerade produkter så är risken större för en hög anti biotikaanvändning. Detta främst på grund av en annan syn på djurvälfärd och antibiotika användning i många länder. Vi behöver därför vara mycket tydliga mot våra leverantörer i vår kravställning och uppföljning – Coop sluter speci fika avtal med enskilda leverantörer och revisionen gäller dessa enskilda leverantörer.
Spanien är ett av de länder som har högst an vändning av antibiotika i Europa. När vi besökte Coops leverantör av medelhavschark i Spanien 2016 såg vi flera exempel på antibiotikaanvändning som vi inte hade sett i Sverige. Leverantören tillsatte antibiotika i fodret till alla smågrisar, använde bred spektrumantibiotika i väntan på analyssvar vid sjuk dom, samt uppvisade bristfällig kunskap och likaså saknades övervakning. Detta är dock ett exempel som gäller just denna leverantör och det finns inte anledning att dra alla spanska leverantörer över en


kam. Det som framkom var inte alls i linje med den svenska branschöverenskommelse med våra leveran törer som vi hade skrivit under, gällande ansvars full antibiotikaanvändning. Vi tydliggjorde därför våra krav gentemot vår spanska leverantör och sa att om de skulle fortsätta som leverantör till oss så krävde vi en kraftig förbättring. När vi sedan gjorde vårt uppföljande besök hos leverantören såg vi en skillnad som nästan var svår att förstå. Nu hade de ingen förebyggande behandling med antibiotika, de hade satt tydliga mål att minska användningen av antibiotika samt infört ett övervakningssystem. Leverantören kunde visa resultat på kraftig minsk ning av antibiotikaanvändning på bara två års tid. Vi fick ett omedelbart bevis på att våra krav kan göra skillnad.
Miraklet som skapat ett monster – antibiotikaresistens/AMR med fokus på djur
När den spanske leverantören fått kraven fråga om antibiotikaanvändning och djurhållning tydliggjorda inträdde en närmast oförståelig för bättring – ett omedelbart bevis på att krav kan göra skillnad. Foto: Ylva Nordin.
15 EN PLATTFORM FÖR NYA PERSPEKTIV
Majsan Pense & Mattis Bergquist
Framgångsfaktorer
Framgångsfaktorerna för vår leverantör var att de börjat arbeta mycket mer med bättre djurvälfärd samt med vaccinering. Djuren föds upp enligt ett djurvälfärdskoncept som bland annat innebär att varje djur har mer utrymme, ingen kastrering förekommer och fixeringen av suggan är begränsad. Med övervakningssystemet rapporterar gårdarna all användning av antibiotika och de kan följa sta tistiken över året och se om de behöver sätta in extra resurser. God djurvälfärd, vaccinering och övervak ning av antibiotikaanvändning har varit nyckeln till den lyckade omställningen hos vår leverantör i Spanien.
Djurvälfärd och behovet av att använda anti biotika är väldigt nära sammankopplat och Coop arbetar därför med en helhet där både djurvälfärd och antibiotika ingår. Vi ställer höga krav på god djurvälfärd och när vi köper importerade produk ter upprättar vi egna leverantörskrav som går utöver EU-lagstiftningen. Dessa krav omfattar exempelvis reglering av fixering av suggor, svanskupering av gris, bedövning vid kastrering och avhorning. Som en del i detta ställer vi även krav på ansvarsfull antibiotika användning i enlighet med Axfoundations kriterier. Leverantörerna ska kunna visa dokumentation på sin antibiotikaanvändning, en plan för reduktion och en faktisk minskning över tid. Leverantörer som inte kan visa det får inte sälja sina produkter hos Coop. Coops arbete gällande antibiotika fokuseras till produkter med importerad råvara, även om dessa står för en väldigt liten del av de produkter som vi säljer. För att lyckas med stora omställningar i primärproduktionen är långsiktiga åtaganden helt avgörande.
Long tail-konceptet
Ett annat exempel är att Coop tillsammans med några utvalda grisuppfödare i Nederländerna startat ett koncept som vi benämner ”long tail”. Förutom krav på kortare fixering av suggorna, ingen kastre ring, mer utrymme, sysselsättning, etc., så kontrol leras det även att inga svansar kuperas. En annan del i detta är även att antibiotika inte får användas. Men om ett djur blir sjukt och behöver behandlas med antibiotika så gör man självklart det. Det är viktigt att sjuka djur får den behandling som krävs.
För att grisuppfödarna skulle våga gå in i detta koncept beslutade Coop att vi skulle betala mer för
varje gris och vi åtog oss dessutom att vi skulle köpa hela grisen. Det innebär att vi inte bara köper exempelvis fläskfilén utan att vi tar hand om hela djuret inklusive charkråvaran. Charkråvara från dessa gri sar skickas till andra utvalda producenter i Europa som tillverkar våra produkter, till exempel korvar eller skinkor. När vi från Coops sida gjorde detta åtagande och gav uppfödarna en trygghet i att deras omställning skulle löna sig beträffande hela grisen och inte endast när det gällde filén så vågade de ställa om sin produktion.

Det uppfödarna i Nederländerna upplevde gan ska snart efter införandet av vårt gemensamma djur välfärdsprogram var att det inte är så svårt som de trodde att föda upp grisar med god djurvälfärd och en mycket låg antibiotikaanvändning. Det var till och med mer lönsamt för dem eftersom grisarna växte mycket bättre. Numera köper vi från Tyskland med samma koncept och krav. Detta är ett ytter ligare bevis på att vi i Sverige kan göra skillnad. Kunskapen om hur man föder upp djur på ett håll bart sätt med en god djurvälfärd och låg antibiotikaanvändning börjar sprida sig och Sverige har en vik tig del i att visa vägen.
Kungl. Skogs- och Lantbruksakademiens TIDSKRIFT
16
2022 EN PLATTFORM FÖR
PERSPEKTIV
nr 5
NYA
Inom Long tail-konceptet kontrolleras att inga svansar kuperas. Foto: Silar, CC BY-SA 4.0.
Antibiotikafria livsmedel – kan det vara annat än bra?
Susanna Sternberg Lewerin
Märkning av animaliska livsmedel som ”antibio tikafria” blir allt vanligare åtminstone internatio nellt. Att de livsmedel som når konsumenten inte innehåller antibiotika eller andra läkemedel är dock en självklarhet i vår del av världen. Regelverk om karenstider säkerställer att tillräcklig tid har passe rat innan djur slaktas, mjölk eller ägg levereras från djur som behandlats. I fattiga länder förekommer det däremot att karenstider inte efterföljs, av okun skap eller för att animaliskt protein är en bristvara och man helt enkelt inte har råd att kasta livsmedel.
Märkningen kan bli missvisande
Antibiotikafria livsmedel är alltså något som svenska konsumenter kan ta för givet. Märkning av livs medel som ”antibiotikafria” blir därför missvisande. Märkningen används ofta för att visa att det en skilda djuret inte behandlats med antibiotika, andra djur i besättningen kan dock ha fått sådan behand ling. Beroende på land och djurslag kan märkningen också betyda att det enskilda djuret inte behandlats med antibiotika en viss tid före slakt, eller under en viss del av uppfödningstiden, men behandling kan ha skett i tidigare skede. Att märka fläskkött som antibiotikafritt för att grisarna inte behandlats under den sista månaden före slakt, som en sorts förlängd karenstid, torde inte imponera på svenska konsumenter men är i praktiken vad vissa franska och italienska konsumenter betalar ett högre pris för.
Detta är i sig inte dåligt, att kunna ta ut ett högre pris för sådana produkter kan fungera som en morot i länder med hög antibiotikaförbrukning och göra att djurägarna vågar investera i förebyggande åtgär der som förbättrar djurhälsan och minskar behovet av antibiotika.
Problemet är snarare att det är svårt för den en skilda konsumenten att bedöma värdet och den lång siktiga effekten av olika ”antibiotikafri”-märkningar.
Om inte märkningen leder till en tydlig förbättring av djurhälsan och en kraftig minskning av antibiotikaanvändningen gör den ingen nytta i kampen mot antibiotikaresistens. Förekomsten av resistenta bakterier och enskilda resistensgener i djurens när miljö gynnas av all antibiotikaanvändning, och även om enskilda djur inte behandlas kommer de ändå att exponeras för resistenta bakterier och antibiotikares ter i urin och gödsel från behandlade djur.
Skälet till att ifrågasätta ”antibiotikafri” märk ning är alltså att den är missvisande. Den kan leda konsumenter att tro att livsmedel utan sådan märk ning faktiskt kan innehålla antibiotika, men djuret som produkten härrör från kan ändå ha varit ex ponerat för antibiotika som givits till andra djur i besättningen. Dessutom säger märkningen inget om djurhållningen i övrigt och det finns fler aspekter än risken för antibiotikaresistensutveckling som är viktiga för konsumenterna. Vi talar om konsumen ternas makt att påverka produktionen men det kan samtidigt tyckas orimligt att jag som konsument själv, baserat på en rad olika märkningar och annan information, ska behöva välja ut och optimera den kombination av faktorer som visar att djurhållning en motsvarar vad jag själv ser som önskvärt avse ende klimatpåverkan, djurvälfärd, etc. Ursprungsmärkningar bör därför ta ett helhetsgrepp och omfatta en rad faktorer som tydligt kan redovisas för konsumenten, kontrolleras av myndigheter eller certifieringsorgan och beskrivas med avseende på för konsumenterna angelägna aspekter såsom miljöpåverkan, djurvälfärd, bidrag till grad av påverkan på antibiotikaresistensutveckling med mera.
Märkningen måste vara pålitlig Märkningar måste också gå att lita på, om konsu menterna ska vilja betala det (oftast) högre priset för en produkt som kanske inte skiljer sig i faktiska egenskaper såsom smak, hållbarhet och andra på
Miraklet som skapat ett monster – antibiotikaresistens/AMR med fokus på djur
17 EN PLATTFORM FÖR NYA PERSPEKTIV
”Antibiotikafri”-märkningen kan göra nytta i regioner med hög användning av antibiotika till djur. Men i regioner med ansvarsfull antibiotikaanvändning och god djurhållning innebär den främst att konsumenterna betalar mer för något de får ändå. Illustration: Vectorjuice on Freepik.

tagliga aspekter, utan där valet grundas på en tilltro till att produktionen i tidigare led är bättre än för den produkt som saknar märkningen. Inget system är perfekt och enskilda dåliga exempel riskerar att förstöra tilltron till en märkning, men en märkning som grundas på existerande regelverk och tillsyn tor de upplevas ”stabilare” än en märkning som grundas på enskilda producenters frivilliga efterlevnad. Ett exempel är märkning av animaliska livsmedel med ursprung i Sverige – den innebär att djuren fötts upp enligt svenska regler för till exempel djurskydd och antibiotikaanvändning.
Hög antibiotikaanvändning inom djurproduk tionen i vissa länder är problematiskt av flera skäl. Dels används förmodligen antibiotika för att hantera hälsoproblem som kan förebyggas med god djurhållning – i dessa fall är den höga användningen ett djurvälfärdsproblem. Dels leder all användning av anti biotika till selektion av resistenta bakterier och ju

mer som används desto mer utbredd blir förekomsten av sådana bakterier. Antibiotikaresistens blir sedan ett problem om den ”smittar” till sjukdoms framkallande bakterier, så att infektioner som beror på sådana hos djur och människor inte går att be handla. Hög användning av antibiotika driver alltså på utvecklingen och spridningen av antibiotikaresistens och det är insikten om detta som också öppnat marknaden för ”antibiotikafria” livsmedel. Framgången för denna märkning visar att det finns en medvetenhet om riskerna med hög antibio tikaanvändning och att konsumenternas efterfrågan faktiskt påverkar hur djurproduktionen bedrivs. Det är i grunden positivt och märkningen kan som sagt göra nytta i regioner med hög användning av anti biotika till djur. Däremot är det svårt att se att den tillför något i regioner med ansvarsfull antibiotika användning och god djurhållning, annat än att kon sumenterna betalar mer för något de kan få ändå.
Kungl. Skogs- och Lantbruksakademiens
18
nr 5 2022 EN PLATTFORM FÖR NYA PERSPEKTIV
TIDSKRIFT
Antibiotikaresistens – ett hot mot folkhälsan som kan hanteras om viljan finns
Åsa Domeij Diskussionen om ett hå llbart livsmedelssystem ä r livlig. Ofta ä r det fokus på klimatet men även bio logisk mångfald, v ä xtnä ringsf örsörjning och kemi kalier ä r centrala delar som diskuteras. Även sociala frågor i leverantörsleden, framf ör allt nä r det g ä l ler produkter från fattigare länder, blir ofta belysta. Alla vet att det man äter kan påverka hä lsan. Men hur många tänker på att anv ändningen av antibio tika inom animalieproduktionen har en påverkan på möjligheterna till en fungerande sjukv å rd genom att en hög antibiotikaanv ändning orsakar att bak terier anpassar sig och blir resistenta? Anv ändning av antibiotika till friska djur i animalieproduktionen riskerar att f örsv å ra eller omöjliggöra behandling av vanliga infektioner eller stötta avancerad cancerbe handling med antibiotika. Sådan användning för bjöds i Sverige 1986, men är fortfarande vanlig i länder som vi importerar livsmedelsprodukter ifrån. Handeln har en viktig roll i att sprida kunskap om
att matproduktion faktiskt kan riskera att drabba vården genom att den livsviktiga antibiotikan inte lägre fungerar och genom att ställa krav på leveran törerna.
Den nya mirakelmedicinen
Antibiotikans historia är nästan ett sekel. Skotten Alexander Fleming upptäckte penicillin 1928. Det är ganska ofta forskningen går framåt på grund av upptäckter som tillkommer av en slump. Så var fal let också den här gången. Fleming hade inför en ledighet diskat slarvigt och lämnat en bakterieod ling. Senare märkte han att en svamp ur släktet penicillium hade dödat bakterier. Han fortsatte att forska och i början på 1940-talet användes penicil lin för första gången på människor. Under andra världskriget användes det på soldater med sårska dor och för att häva svåra infektioner. Efter kriget fick civila stegvis allt bättre tillgång till penicillin. Mänskligheten hade av en ren slump fått tillgång till en mirakelmedicin mot bakterieinfektioner. Idag finns det många olika sorters antibiotika att välja på. Dessvärre finns det känd resistens mot dem alla.

Introduktion av antibiotika inom svenskt lantbruk
På 1950-talet upptäcktes det att djur inom lantbru ket växte snabbare om de fick en tillsats av antibio tika i fodret. Efter det ökade användningen inom djurhållningen. Redan nästföljande decennium de batterades risken med att den stora användningen inom såväl humanmedicin som inom djurhållningen orsakade resistens mot antibiotika. Det dröjde till 1980-talet innan reglerna kring användningen skärptes i Sverige. Då blev hållbarhetsfrågor, även om begreppet hållbarhet inte användes, en viktig del av samhällsdebatten. Jordbruksproduktionen kriti serades bland annat för kemikalieanvändning och
Miraklet som skapat ett monster – antibiotikaresistens/AMR med fokus på djur
19 EN PLATTFORM FÖR NYA PERSPEKTIV
Sir Alexander Fleming upptäckte penicillinet av en slump år 1928. Efter fortsatt forskning började penicillinet att användas på människor 1941. Målning: Ethel Leontine Gabain, Public domain.
att antibiotika användes i tillväxtfrämjande syfte och inte för att bota sjuka djur.
Helt i enlighet med tidsandan fattade riksdagen 1985 beslut om att komplettera jordbrukspolitiken med ett miljömål. Även LRF ville ha begränsning ar av antibiotikaanvändningen. År 1986 trädde en ändring i foderlagen i kraft, antibiotika i tillväxt befrämjande syfte förbjöds. Riksdagsbeslutet var nästan enigt. Det fanns oro för både djurhälsan och för den svenska produktionens konkurrenskraft och därför röstade Moderaterna nej. I några år steg användningen av antibiotika, för att sedan minska kraftigt tack vare höjd kompetens och satsningar på smittskydd och djurvälfärd. Idag är den låga anti biotikaanvändningen en viktig del av de mervärden som finns inom svenskt jordbruk och som stärker konkurrenskraften.
Antibiotika inom lantbruket idag i ett internationellt perspektiv
Inom EU är Sverige tillsammans med Finland det land som använder minst antibiotika i djurhåll ningen och det finns ingen anledning till att övriga länder inte ska kunna komma ned till samma låga nivå. För att lyckas krävs satsningar på djurvälfärd och en strategi som gör det möjligt att arbeta med djurhälsa och minimera gruppbehandling av djur med antibiotika. De flesta konsumenter skulle an tagligen bli upprörda om de förstod att antibiotika användningen inom jordbruket är ett stort hot mot modern sjukvård.
Handeln har ett stort ansvar för de varor som säljs på marknaden. År 2013 påbörjade Axfoundation, på initiativ av Axfood, ett arbete med att ta fram riktlinjer för de varor som erbjuds konsumenterna i samarbete med dagligvaruhandeln. Anledningen till att arbetet kom i gång då var att EU:s läkeme delsmyndighet hade publicerat statistik för anti biotikaanvändning inom jordbruket inom EU och EES. Statistiken visade på hög användning inom jordbruket i EU och att det fanns stora skillnader mellan olika länder. Dessa skillnader visade också att det fanns en stor potential att minska använd ningen. Resultatet av initiativet blev gemensamma kriterier för antibiotika för alla medlemmar i Svensk Dagligvaruhandel. År 2020 uppdaterades kriteri erna och det säkerställdes att de också fungerar för vattenbruk.
Handelns utmaningar
Kriterierna för antibiotikaanvändning har haft stor praktisk betydelse genom att både öka kompetensen inom livsmedelsbranschen och ställa krav på pro ducenterna. Men arbetet innebär stora utmaningar. En svårighet är att få konsumenterna att förstå frå gan. Problemet är inte rester av antibiotika i maten, utan att antalet resistenta bakterier ökar generellt och att det är ett hot mot den moderna sjukvården. Vid marknadsföring av produkter är det lättare att kommunicera att något är antibiotikafritt än att för klara att man arbetar för en förnuftig och försiktig användning av antibiotika. Om man driver en pro duktion som siktar på att sälja produkter som ”anti biotikafria” så kommer det att hända att djur ibland blir sjuka. Då måste man ändå ge dem antibiotika även om de inte kan säljas som ”antibiotikafria”. Begreppet kan leda tanken fel och förleda konsu menterna att tro att problemet är att det kan finnas antibiotika i produkterna när det stora problemet i stället är den antibiotikaresistens som försvårar för vården.
En utmaning för handelns kvalitetsavdelningar är att kontrollera att antibiotikakriterierna följs. Kriterierna innebär bland annat att antibiotika all tid ska förskrivas av veterinär och dokumenteras. Dessutom ska friska djur inte behandlas utom om det är synnerligen motiverat. Vid korrekt antibiotikabehandling av livsmedelsproducerande djur gäller inom EU lagstadgade karensregler som garanti för att livsmedel är fria från antibiotikarester. Därför är det inte tillräckligt att kontrollera eller mäta nivåer i sjä lva produkterna. När det gäller användningen av antibiotika är det nämligen mer fråga om produk tionskvalitet än produktkvalitet. Produktkvalitet är sådant som är mätbart i själva produkterna, till ex empel att en fiskprodukt innehåller rätt fiskart eller att en frukt är fri från otillåtna bekämpningsmedel. Kontrollerna sker genom provtagning och laborato rietester. Produktionskvalitet handlar om att göra en kontroll hela vägen ut till den enskilda bonden för att säkerställa att de krav som ställs verkligen efter levs. Det bästa vore en certifiering för livsmedelsproduktion som täcker in de krav som handeln stäl ler. Certifieringen kunde krävas vid upphandling och bönderna skulle behöva certifiera sin produktion på gårdarna genom ett certifieringsbolag.
När frågor ställs till leverantörerna inför en upp handling är det viktigt att frågorna är begripliga så
Kungl. Skogs- och Lantbruksakademiens TIDSKRIFT nr 5 2022
20
EN PLATTFORM
PERSPEKTIV
FÖR NYA
att svaren blir relevanta och användbara. Där har utvecklingen gått i rätt riktning. Det är inte längre lika vanligt att leverantörer till exempel svarar på om produkterna innehåller antibiotika när det egentli gen handlar om hur och i vilken omfattning antibio tika används i produktionen. Skillnader förekommer också mellan leverantörer. De som ligger nära själva primärproduktionen är mest insatta, medan de som finns längre bort i livsmedelskedjan och arbetar med sammansatta livsmedel ibland inte är lika insatta. Sammansatta varor kan till exempel vara färdigrätter som innehåller många olika råvaror som köps in från många underleverantörer.
I antibiotikakriterierna är kraven på dokumenta tion viktiga. De kan i praktiken vara svåra att följa upp genom kontroll på varje enskild gård. Den ty pen av uppföljning måste i stället göras stickprovsvis och detta visar på hur angeläget det är med en antibiotikacertifiering. Något som skulle kunna förbättra riskbedömningen i olika länder är om det funnes statistik över antibiotikaanvändningen som är uppdelad på olika djurslag och inte bara visar den totala användningen. Inom EU är man väl medveten om problemet och arbetar i den riktningen.
Antibiotikakriterierna har fått många praktiska och positiva konsekvenser. Kompetensen har höjts inom livsmedelsbranschen, vilket har påverkat vilka affärer som görs. Särskilda riskländer undviks i prak tiken även om bedömningen görs på leverantörsnivå. Artiklar som kommer från produktionsformer som
kräver mycket antibiotika undviks helt. Intressant är också att kriterierna har höjt medvetandet ge nerellt och bidragit till en debatt om antibiotikaanvändningen som fått betydelse. Grillost från Sverige hade knappast blivit ett så populärt alternativ till halloumi om inte användningen av antibiotika på Cypern hade diskuterats.

Förhoppningar inför framtiden Att EU allt oftare lyfter fram problemet med anti biotikaresistens inger hopp. I handlingsplanen ”One Health mot antimikrobiell resistens” tas problemet upp om att antibiotika används förebyggande för att kompensera för dålig hygien inom lantbruket. EU kommer att skärpa kraven på användningen av anti biotika ytterligare vilket gör att medlemsländerna också tar initiativ inom smittskydd och djurvälfärd. Men det är bråttom, det går för sakta inom EU. I andra delar av världen är problemet ännu större. Det borde till exempel inte vara tillåtet att använda anti biotika till alla djur nästan regelmässigt i en produk tion. För att framgångsrikt förändra och minimera användningen av antibiotika inom lantbruket är ini tiativ inom näringslivet viktiga. Skärpt lagstiftning och ytterligare krav för internationell handel är helt nödvändiga. Antibiotikaresistens är ett av de största hoten mot folkhälsan världen över men det kan han teras om bara viljan finns.
Miraklet som skapat ett monster – antibiotikaresistens/AMR med fokus på djur
21 EN PLATTFORM FÖR NYA PERSPEKTIV
Cypriotisk halloumi. Sommaren 2019 kom rapporter om hög antibiotikaanvändning i samband med animalieproduktion på Cypern. Det ledde till att många i Sverige valde bort halloumi till förmån för svensk grillost. Foto: Anatoliy Smaga, CC BY-SA 4.0
Antibiotika inom växtodlingen
Sofia Toftebrant
Användning av antibiotika inom human- och djur medicin har fått stor uppmärksamhet de senaste åren på grund av risken för ökad utveckling och spridning av antibiotikaresistens till människor och djur. Däremot är det få länder som har belyst och dokumenterat användningen av antimikrobiella äm nen inom växtodlingen trots att det finns en oro över att även denna typ av användning kan påskynda ut veckling och spridning av resistenta bakterier, bland annat genom livsmedel.
En ny uppseendeväckande undersökning visar att hela 83 procent av 158 tillfrågade länder inte kunde bedöma den nationella användningen av antimikro biella medel på växter och endast 11 procent angav att de kunde uppskatta sin användning baserat på nationell och regional försäljning (FAO and WHO, Monitoring global progress on addressing antimicrobial resistance, 2019). Bristen på övervakning och doku mentation gör det svårt att få en uppskattning av den globala användningen och vad det kan ha för effekter för människor, djur och miljö. Denna artikel sammanställer forskning som finns inom området i syfte att ge en tydligare bild av användningen av antibiotika inom växtodlingen globalt.
Stora skillnader gällande lagstiftning Europeiska unionen (EU) är en av de regioner som inte godkänner antibiotika som växtskyddsmedel. Dock har EU gjort undantag i ett fåtal fall och nödsituationer där vissa förbjudna växtskyddsmedel får användas för att bekämpa sjukdomar, då det inte finns några andra tillgängliga behandlingar. Dessa volymer ska dock vara väldigt små och användningen är strikt kontrollerad.
USA är en av de regioner som använder antimikrobiella ämnen i större utsträckning och där har man använt antibiotika inom växtodling sedan 1950-talet för att kontrollera olika sjukdomar hos växter. Så sent som år 2016 godkände Environmental Protection Agency (EPA) användning av två kritiskt viktiga antibiotika för människor för akut behand ling av växter som fått sjukdomsutbrott. Sedan dess har bestämmelserna för ett av dessa ämnen utökats till att det får användas som rutinbehandling på citruslundar i Florida och Kalifornien, vilket innebär att antibiotikan kan användas utan att myndigheten behöver utfärda sina nödundantag. Detta godkän nande har fått stor uppmärksamhet i USA och för väntas öka användningen av antibiotika avsevärt.
En kort förklaring till de begrepp som används återkommande i artikeln
• Växtskyddsmedel – ett samlingsnamn för bekämpningsmedel som används i huvudsak för att skydda växter och växtprodukter inom jordbruk, skogsbruk och trädgårdsbruk. Växtskyddsmedel används exempelvis mot svampangrepp, skadedjur eller konkurrerande växter. Det finns både växtskyddsmedel som är godkända och sådana som inte är godkända. Detta skiljer sig åt i olika länders lagstiftning.
• Antimikrobiella ämnen – en del av de medel som ingår i begreppet växtskyddsmedel. Antimikrobiella ämnen inkluderar läkemedel som används för att förebygga och behandla infektioner hos människor, djur och växter orsakade av till exempel bakterier, virus, svampar eller parasiter.
• Antibiotika – en del av de medel som ingår i begreppet antimikrobiella ämnen. Antibiotika är läkemedel som primärt används för att behandla sjukdomar som orsakas av bakterier.
• Svampmedel – en del av de medel som ingår i begreppet antimikrobiella ämnen. Svampmedel är läkemedel som används för att behandla sjukdomar som orsakas av svamp.
Kungl. Skogs- och Lantbruksakademiens TIDSKRIFT
22
2022 EN PLATTFORM FÖR NYA PERSPEKTIV
nr 5
Utöver EU och USA är det svårt att kartlägga hur användningen av antimikrobiella ämnen på växter och grödor ser ut. De flesta är dock överens om att minst 20 länder utanför EU godkänner antimikrobiella ämnen inom växtodling, främst låg- och medelinkomstländer. Det har bland annat obser verats att antibiotika rekommenderas i länder i Amerika, östra Medelhavet, sydöstra Asien, västra Stilla havet samt i Kina.
Varför används antimikrobiella ämnen i växtodling?
Antimikrobiella ämnen rekommenderas till över 200 unika diagnoser och sjukdomar hos växter runt om i världen, där den främsta anledningen till att använda antibiotika är att kontrollera och bekämpa olika typer av bakteriella växtsjukdomar. De två vanligaste sjukdomarna orsakade av bakterier är Fire blight och huanglongbing (HLB). Fire blight orsakas av den fytopatogena bakterien Erwinia amy lovora som oftast drabbar äppel- och päronträd och tar död på hela eller delar av växten medan HLB gör så att frukterna faller av träden innan de är mogna. Utöver bakteriella växtsjukdomar rekommen deras antibiotika även som behandling för sjukdom som tros ha orsakats av en insekt eller kvalster. Detta är överraskande eftersom antibiotika inte kan bota sådana sjukdomar. Det är också vanligt att rekom mendera antibiotika som behandling mot olika svampsjukdomar då vissa typer av antibiotika (till exempel streptomycin, kasugamycin, aureofungin,
ningnanmycin, oxolinsyra och validamycin) även är effektiva mot svampsjukdomar.
Hur mycket antimikrobiella ämnen används?
Bristen på tillförlitliga data gör det mycket svårt att beräkna den globala användningen av antimikrobiella ämnen inom växtodling. Dock uppskattas mängden vara relativt låg jämfört med mängden inom djursjukvård.
För ungefär 10 år sedan uppskattades använd ningen på växter uppgå till 0,26–0,5 procent av den totala antibiotikakonsumtionen i jordbruket. Nyare uppgifter har det inte hittats några studier om.
Växter och grödor som behandlas Antimikrobiella ämnen används på flera olika väx ter runt om i världen, bland annat på äpplen, päron, citrusfrukter (apelsiner och grapefrukt), stenfrukter (nektarin och persika), ris, tomat, potatis, blomkål, broccoli, vattenmelon, kiwi, selleri, peppar och bönor. I låg- och medelinkomstländer identifierades anti biotikarekommendationer till över 100 olika grödor där den vanligaste var ris.




Det fanns dock stora regionala skillnader. Till exempel fanns inga risgrödor representerade i data från Amerika medan länder i sydöstra Asien rekom menderade antibiotika till 7,4 procent av sjukdoms fallen på risplantor (Taylor, P. & Reeder, R., 2020). Denna stora skillnad beror troligtvis på att det i
Miraklet som skapat ett monster – antibiotikaresistens/AMR med fokus på djur
23 EN PLATTFORM FÖR NYA PERSPEKTIV
Huanglongbing drabbar citrusträd. Foton: Gottwald/Garnsey, Public domain, och M. Macbeth, CC0.
Fire blight-symptom på äpple. Foton: Scot Nelson, CC0, och I. Paethon, CC BY-SA 3.0.
Asien är godkänt att använda antibiotika mot ”rice blast desease”, en sjukdom orsakat av svamp (FAO, 2020). När ris togs bort från beräkningarna mins kade andelen rekommendationer som innehöll anti biotika i sydöstra Asien till endast 0,6 procent.


Olika typer av antimikrobiella ämnen Antimikrobiella medel som används som bekämp ningsmedel för växtsjukdomar består bland annat av antibiotika och svampmedel. Det finns en rad olika antimikrobiella medel som används inom växtodling, där streptomycin och oxytetracyklin är de vanligaste typerna. Men även tetracyklin och kasugamycin anses bli använda i stor utsträckning. Av de antimikrobiella ämnen som används på växter anses sju av dem (streptomycin, tetracyklin, oxyte tracyklin, gentamicin, cefadroxil, amoxicillin och oxolinic acid) som viktiga antimikrobiella läkemedel för människor enligt WHO.
Applicering
Det vanligaste sättet att applicera antibiotika på växter och grödor är genom spraybehandlingar där antibiotikan löses upp med vatten och sedan sprayas som en dimma över växterna. Problematiken med denna metod är att endast en liten del av ämnet tas upp av växterna och uppskattningsvis förloras så mycket som 44–71 procent av lösningen till miljön runt omkring vilket kan påverka både djur, människor och omgivning.
En annan metod är att injicera antibiotika direkt i stammen. I dessa fall borras ett hål i stammen ungefär 50–70 cm ovanför marken, där sprutor eller droppflaskor med antibiotikalösningen sätts in. Enligt studier anses detta vara den mest effektiva me toden för att bekämpa växtsjukdomar orsakade av bakterier eftersom ämnet kommer direkt in i väv naderna där bakterierna finns. Anledningen till att inte fler länder använder staminjektion beror troligt vis på att man har hittat höga halter av antibiotika i frukter från träd som har staminjicerats.
Riskerar användningen att påskynda resistensen?
Användningen av antimikrobiella ämnen i växt odlingen har två konsekvenser för resistensutveck lingen. Den första är att patogenerna i växterna utvecklar en resistenskraft mot de antimikrobiella ämnena som används som växtskyddsmedel. Denna konsekvens är väl studerad och kunskapen om den etablerad. Den andra konsekvensen är att med den ökade användningen av antimikrobiella ämnen så ökar förekomsten av resistensgener i växtodlings miljön och därmed ökar risken för överföring av resistensgener till bakterier hos människor och djur. Detta förhållande är mycket mindre känt och enligt FAO och WHO är det osäkert i vilken utsträckning antimikrobiella ämnen som används som bekämp ningsmedel i växtproduktionen bidrar till resistens hos människor och djur.
Det finns dock en stor oro idag över använd ningen av antibiotika inom jordbruket, på grund av risken för att resistens ska sprida sig till och drabba även humanmedicinskt viktiga antibiotika. Hittills har farhågorna främst baserats på användningen inom djurhållningen och användningen inom växt odling har i stort sett inte kommenterats. Möjligen för att användningen hittills bedömts vara mycket låg i jämförelse med mängderna inom djurhållning,
Kungl. Skogs- och Lantbruksakademiens TIDSKRIFT nr 5 2022
24
EN PLATTFORM FÖR NYA PERSPEKTIV
Rice blast disease orsakas av svamp och bekämpas med antibiotika i sydöstra Asien. Foton: Donald Groth, Public domain, och Coentor, CC BY-SA 3.0.
eller för att det medicinska samfundet inte varit medvetet om användningen i detta avseende.
När det gäller risken för resistensöverföring mellan växter och människor bedöms den vara låg i de flesta länder, särskilt de med starka regleringar och där antibiotikaanvändningen är mycket låg el ler obefintlig. Risken är sannolikt högre i produkter från länder där användningen av antimikrobiella ämnen inte rapporteras, även om det är svårt att be döma risken mer exakt.
Denna artikel bygger på rapporten ”Antibiotika till apelsiner?” från Axfoundation.
Läs gärna mer i Axfoundations rapport Antibiotika till apelsiner?: https://www.axfoundation.se/framtidens-mat/antibiotika-till-apelsiner

Referenser
Archer, L., Albrecht, U. & Roberts, P. 2020. Antibiotics in crop production. https://edis.ifas.ufl.edu/publication/hs1366
Chanvatik, S., Donnua, S., Lekagul, A., Kaewkhankhaeng, W., Vongmongkol, V., Athipunyakom, P., Khamlar, S., Prommintara, M., & Tangcharoensathien, V. 2019. Antibiotic use in mandarin production (Citrus reticulata Blanco) in major mandarin-producing areas in Thailand: A survey assessment. PloS one, 14(11) https://www.ncbi.nlm.nih.gov/pmc/articles/PMC6853317/
FAO. 2020. Antimicrobial Resistance (AMR) in relation to pesticide use in plant production. https://www.fao.org/3/cb0660en/ CB0660EN.pdf
Haynes, E., Ramwell, C., Griffiths, T., Walker, D. & Smith, J. 2020. Review of Antibiotic Use in Crops, Associated Risk of Antimicrobial Resistance and Research Gaps. https://www.food.gov.uk/sites/default/files/media/document/review-of-antibiotic-use-incrops-associated-risk-of-antimicrobial-resistance-and-research-gaps-final.pdf
Killiny, N. & Vincent, C. 2021. Antibiotic Delivery Methods: Trunk Injection vs. Foliar Application. https://citrusindustry. net/2021/04/19/antibiotic-delivery-methods-trunk-injection-vs-foliar-application/ Regulation (EC) no 1107/2009 of the European parliament and of the council. http://extwprlegs1.fao.org/docs/pdf/eur103352.pdf
Sundin, G.W. & Wang, N. 2018. Antibiotic Resistance in Plant-Pathogenic Bacteria. Annu. Rev. Phytopathol, 56. https://www.stopamr. eu/wp-content/uploads/2019/11/antibiotic-resistance-in-plant-pathogenic-bacteria.pdf
Svanström, Å., Bylund, J. & Egervärn, M. Import av livsmedel med potential att sprida antibiotikaresistens – underlag för provtagning. Livsmedelsverkets rapportserie nr 36/2017. https://www.livsmedelsverket.se/globalassets/publikationsdatabas/rapporter/2017/import-avlivsmedel-med-potential-att-sprida-antibiotikaresistens_livsmedelsverkets-rapport-36-2017.pdf?AspxAutoDetectCookieSupport=1
Taylor, P & Reeder, R. 2020. Antibiotic use on crops in low and middle-income countries based on recommendations made by agricul tural advisors. CABI Agric Biosci 1 (1) https://cabiagbio.biomedcentral.com/articles/10.1186/s43170-020-00001-y WHO. 2018. Critically important antimicrobials for human medicine. https://www.who.int/publications/i/item/9789241515528
Miraklet som skapat ett monster – antibiotikaresistens/AMR med fokus på djur
25 EN PLATTFORM FÖR NYA PERSPEKTIV
Stora risker när intressen krockar
Englund
I en perfekt värld har vi fungerande antibiotika som bara används när de verkligen behövs. Medicinerna är billiga och tillgängliga och tillverkas riskfritt i enlighet med gemensamma kvalitetskrav. Så fung erar det tyvärr inte idag. Det finns alltför många in tressenter, regelverk och länder som för närvarande inte arbetar mot samma mål. När en veterinär eller läkare skriver ut ett preparat som innehåller anti biotika har de ingen information om varifrån råva rorna till medicinen kommer, bara var slutprodukten tillverkats. Därför är det inte möjligt för förskrivare och brukare att göra medvetna val på samma sätt som man kan när man köper exempelvis ursprungs märkt kött.
Åtgärder för att minska antibiotikaresistens i an vändarleden diskuteras i många sammanhang, inte minst i denna tidskrift. När man blickar längre bort och försöker begränsa riskerna för uppkomst och spridning av antibiotikaresistens i produktionsked jan för läkemedel till djur och människor är listan på potentiella aktörer både lång och global, vilket bland annat beskrivs i en läsvärd och tankeväckande rap port från changingmarkets.org 2016: Superbugs in the Supply Chain 1 I vissa länder används låga doser av antibiotika i foder som tillväxtbefrämjande medel och då tillkommer även en komplicerad kedja av tillverkare av fodertillsatser. Sådan användning av anti biotika är dock förbjuden inom EU.
Antibiotika i vatten kan ge upphov till resistenta bakterier
Vattendrag över hela världen, inklusive Sverige, kan innehålla rester av olika typer av aktiva farmakologiska substanser (Active Pharmaceutical Ingredients, API) även efter det att vattnet processats i reningsverk. Substanserna i vattnet kommer från konsumerade mediciner som via urin och avföring hamnar i avloppsvatten, nedspolade mediciner, sjukhusav lopp och från tillverkningsanläggningar.1, 2, 3 Antibiotikarester från animalieproduktion kan också läcka ut i vattendrag. Utsläpp av antibiotika i vatten
drag som också innehåller höga halter av bakterier från bristfälligt renat avloppsvatten utgör en doku menterad risk för överföring av gener för antibiotikaresistens till bakterier som orsakar sjukdom hos människa.4 Där kan alltså ”superbugs” uppstå, det vill säga sjukdomsalstrande bakterier som är mot ståndskraftiga mot de flesta eller alla antibiotikapreparat vi känner till.
De högsta koncentrationerna av antibiotika i vat ten och sediment har dock påvisats i anslutning till anläggningar där API tillverkas. De största tillver karna finns i Indien och Kina. Indien har en uttalad strategi att ytterligare öka sin inhemska produktion av API och intermediära produkter som används vid läkemedelstillverkning för att öka sin andel på den internationella marknaden och minska sitt beroende av import från Kina. Det görs bland annat genom statligt stöd för inrättande av stora industriområ den för läkemedelsproduktion, Bulk Drug Parks.5 Välkända internationella läkemedelsbolag i EU, USA och andra västländer köper API från under leverantörer i Indien (producerade i Indien eller importerade från Kina, figur 1). I mottagarländerna används substanserna för att tillverka många av de läkemedel för djur och människor som vi är bekanta med.
Good Manufacturing Practice (GMP) ställer inga miljökrav För att kunna exportera till dessa reglerade mark nader måste företagen möta kraven för god tillverk ningssed (Good Manufacturing Practice, GMP) som syftar till att användaren ska vara säker på att de får rätt produkt med hög kvalitet.6 GMP inne håller emellertid inga krav på begränsningar eller kontroll av företagens miljöpåverkan genom exem pelvis utsläpp av lösningsmedel och API i vatten drag. Sådana regler, och tillsynen av efterlevnaden, hanteras av de berörda myndigheterna i landet där fabriken ligger.
Miljöfarliga utsläpp, med risk för utveckling och spridning av resistenta bakterier, från fabriker i Kina
Kungl. Skogs- och Lantbruksakademiens TIDSKRIFT nr
26
GLOBAL UTBLICK
5 2022
Lena
och Indien är mer regel än undantag1, 7, 9, 10 och brott mot GMP är inte ovanliga.1
Upphandling kan göra skillnad Inom Sveriges system för läkemedelssubventioner för humanläkemedel gör Tandvårds- och Läkemedelsförmånsverket var tredje månad ett urval av pre parat som kallas ”periodens vara”. Syftet är att hålla nere statens kostnader för läkemedel som är subventionerade och omfattas av högkostnadsskyddet. Apoteken är skyldiga att byta ut de förskrivna pre paraten mot dessa likvärdiga men billigare preparat från ”periodens-vara-systemet”.7 I denna bedömning ingår priset och leveranssäkerheten, men miljöhänsyn eller tillverkningsland för råvarorna eller den färdiga produkten vägs inte in. ”Periodens vara” ut görs oftast av generiska läkemedel, som innehåller samma API, har samma dosering och används för att behandla samma sjukdomar som ett läkemedel som tidigare godkänts (referensläkemedel).
Tillverkarna av generiska läkemedel kan använda sig av data från kliniska prövningar och annan dokumentation som legat till grund för godkännandet av referensläkemedlet. Sådan dokumentation, från det kostnadskrävande ursprungliga utvecklingsarbetet, blir tillgänglig när perioden för dataexklusivitet för referensmedlet har löpt ut, vanligtvis 10–11 år ef ter det första godkännandet av referensprodukten. Generiska läkemedel, däribland de flesta antibiotikapreparat som används till djur och människor, är alltså förhållandevis billiga att tillverka och kan tillverkas av små (under)leverantörer och säljas till
ett lägre pris än referensläkemedlen. Ofta används samma typer av antibiotika till djur som till människor. Indien är en stor exportör av såväl aktiva substanser för läkemedelstillverkning (API) som generiska läkemedel.


Svenska studier pekade på riskerna Svenska forskare publicerade 2007 den första un dersökningen av förekomsten av API i utflödet från ett indiskt reningsverk som bearbetade avloppsvat ten från omkring 90 anläggningar som producerade APIs, intermediära produkter och färdiga läkeme del.8 Halten ciprofloxacin (ett bredspektrumanti biotikum som hör till gruppen kinoloner) i vattnet som släpptes ut efter att ha passerat reningsverket var 28 000–31 000 µg/L vilket kan jämföras med att 0,1 µg/L nyligen har föreslagits som gränsvärde för ciprofloxacin i vatten för att förhindra resistens utveckling.9 De extremt höga koncentrationerna av framför allt kinoloner i vattnet som hade processats i reningsverket visade att reningsprocessen inte var tillräcklig. Dessutom tillfördes avloppsvatten inne hållande urin och avföring under processen, vilket skapade en ständigt närvarande grogrund för resi stenta bakterier. Samma forskare visade två år senare att 71 produkter på den svenska marknaden innehöll API från anläggningar som skickade sitt avlopps vatten till det undersökta reningsverket.10
På uppdrag av Nordea Asset Management publicerades 2016 en rapport över hur farmakologiska föroreningar påverkade samhällen och miljö i två indiska områden med ett mycket stort antal
Miraklet som skapat ett monster – antibiotikaresistens/AMR med fokus på djur
27 GLOBAL UTBLICK
till
Figur 1. Framställningen av de råvaror (längst till vänster i illustrationen) som används av de stora läkemedelstillverkarna i västvärlden sker ofta i länder som Indien och Kina. Där är reglerna avseende miljöpåverkan mindre strikta och tillverkningen av läkemedel inom human- och veterinärmedicin förhållandevis billig. När antibiotika används av läkare och veterinärer, eller blandas i foder, saknas information om var de aktiva substanserna tillverkats och riskerna för resistensutveckling i samband med tillverkningen kan därför inte vägas in vid valet av preparat. Illustration: Lena Englund.
Aktiva substanser (API)
Tabletten, kapseln, lösningen
Övriga ingredienser Förpackning, instruktioner
Framställning av råvaror Tillverkning av läkemedel Distribution och lagring Förskrivning/användning
verkningsanläggningar.11 Man rapporterade hur vissa stora reningsverk ägs av läkemedelsproducen terna och är föremål för mycket begränsad myn dighetskontroll utan effektiva verktyg, eftersom gränsvärden saknas. Illegala utsläpp direkt från fabrikerna sades också vara vanliga. Sammantaget utgör dessa utsläpp en påtaglig risk för utveckling av resistenta sjukdomsorsakande bakterier samt be gränsar möjligheterna till säker livsmedelsproduk tion i regionerna och tillgången till rent dricksvatten för befolkningen. Den tidigare nämnda rapporten, Superbugs in the Supply Chain1, byggde vidare på un dersökningarna som gjorts på uppdrag av Nordea Asset Management och visade att utsläpp av API och riskerna för resistensutveckling sannolikt är ett problem i hela Indien. Rapporten identifierar tre namngivna företag i Hyderabad, Chennai och Delhi som särskilda ”hotspots” för utveckling av resistenta bakterier.
Små steg i rätt riktning Nordea Asset Management stödjer läkemedelspro ducenter som inom Pharmaceutical Supply Chain Initiative (PSCI) har kartlagt sina API-källor och arbetar för en hållbar leverantörskedja där miljö föroreningar och mänskliga rättigheter beaktas. En färsk rapport från Access to Medicine Foundation, Antimicrobial Resistance Benchmark 2021, beskriver hur 17 av världens största läkemedelsföretag har bör jat arbeta för att begränsa uppkomst och spridning av antibiotikaresistens genom att ställa miljökrav (exempelvis genom utsläppsgränser) på sina under-
leverantörer av API men att efterlevnaden hos un derleverantörerna fortfarande är bristfällig.12 Indiens regering publicerade dock i januari 2020 ett lagför slag över gränsvärden för API i utsläpp från far makologiska fabriker.13 Gränsvärdena baserades på dem som föreslagits av svenska forskare. De föreslagna gränsvärdena ligger mycket långt under de koncentrationer som påvisats av internationella fors kare (tabell 1), och gränsvärdena har i mars 2022 ännu inte införts i den nationella miljölagstiftning en. Om sådana gränsvärden verkligen införs i indisk lag och offentlig tillsyn av efterlevnaden kommer i gång kvarstår fortfarande utmaningen att hantera de uppenbara intressekonflikterna mellan dessa statliga miljömål13 och den uttalade statliga satsningen för att öka API-produktionen genom att etablera ytter ligare läkemedelsfabriker i ännu fler indiska stater.5
Vem bär ansvaret? Ansvaret för att minska antibiotikautsläpp, och där med risken för utveckling av multiresistenta sjuk domsorsakande bakterier, från fabriker i länder med svagare reglering vilar alltså huvudsakligen hos de stora läkemedelsföretagen, lagstiftare, inköpare, an vändare och konsumenter i västvärlden.
Vilken instans förhindrar att den nödvändiga ursprungsinformationen görs tillgänglig? Vad har vi för påtryckningsmedel som skulle kunna påverka producentländerna? Är företagen beredda att mins ka vinsterna och är vi andra beredda att betala mer för att behålla effektiva läkemedel?
Kungl. Skogs- och Lantbruksakademiens TIDSKRIFT nr
28
GLOBAL UTBLICK
5 2022
Aktiv substans (API) Påvisat i renat av loppsvatten i Indien µg/L) Gränsvärde i indiskt lagförslag µg/L) Gränsvärde föreslaget av forskare (µg/L) Påvisat i renat av loppsvatten i Sverige µg/L) Ciprofloxacin 28 000–31 000 0,02 0,1 < 0,1 Enrofloxacin (djurläkemedel) 780–900 0,02 Norfloxacin 390–420 0,20 Tabell 1. De höga koncentrationer av tre kinolonantibiotika som påvisats i renat avloppsvatten i Indien8 i relation till de nya gränsvärden som nyligen presenterats i ett indiskt lagförslag13. Som jämförelse listas också ett gränsvärde för ciprofloxacin som föreslagits av forskare för att förhindra resistensutveckling9 samt uppmätta halter i renat avloppsvatten i Sverige3
DDD, definierade dygnsdoser AIP, apotekens inköpspris
Figur 2. Generika, andel av den totala läkemedelsförsäljningen. År 2021 utgjorde generiska läkemedel och biosimilarer 22,7 % av den totala läkemedelsförsäljningen och 66,8 % av försäljningsvolymen mätt i DDD, definierade dygnsdoser. Figuren inkluderar endast humanläkemedel. Källa: IQVIA/Lif, modifierad.
Läsförslag
https://changingmarket.wpengine.com/wp-content/uploads/2016/12/BAD-MEDICINE-Report-FINAL.pdf
Referenser
1. https://changingmarkets.org/wp-content/uploads/2018/01/Superbugsinthesupplychain_CMreport_ENG.pdf
2. Wilkinson J.L. et al. 2022. Pharmaceutical pollution of the world’s rivers. PNAS. https://doi.org/10.1073/pnas.2113947119
3. Östman M. 2018. Antimicrobials in sewage treatment plants. Doctoral dissertation, Umeå University. http://umu.diva-portal.org/smash/get/diva2:1255290/FULLTEXT01.pdf
4. Larsson D.G.J. and Flach C-F. 2021. Antibiotic resistance in the environment. Nature Reviews Microbiology. https://dx.doi.org/10.1038/s41579-021-00649-x
5. Annual report 2020–21, Department of Pharmaceuticals, Ministry of Chemicals and Fertilizers, Government of India. https://pharmaceuticals.gov.in/sites/default/files/english%20Annual%20Report%202020-21.pdf
6. https://ec.europa.eu/health/medicinal-products/eudralex/eudralex-volume-4_en
7. https://www.tlv.se/apotek/utbyte-av-lakemedel-pa-apotek/periodens-varor.html
8. Larsson D.G.J., de Pedro C, Paxeus N. 2007. Effluent from drug manufacturers contains extremely high levels of pharmaceuticals. Journal of Hazardous Materials. https://doi.org/10.1016/j.jhazmat.2007.07.008
9. Kraupner N., et al. 2018. Selective concentration for ciprofloxacin resistance in Escherichia coli grown in complex aquatic biofilms. https://www.sciencedirect.com/science/article/pii/S0160412018300801?via%3Dihub
10. Larsson D.G.J and Fick J. 2009. Transparency throughout the production chain: A way to reduce pollution from the manufacturing of pharmaceuticals? Regul Toxicol Pharm. https://dx.doi.org/10.1016/j.yrtph.2009.01.008
11. https://changingmarkets.org/wp-content/uploads/2017/07/2016-04_pharma-pollution-in-India_small_web_spread.pdf
12. https://accesstomedicinefoundation.org/publications/2021-antimicrobial-resistance-benchmark
13. http://thebureauinvestigates.com/stories/2020-02-07/india-to-ban-antibiotics-pollution-from-pharma-factories
Miraklet som skapat ett monster – antibiotikaresistens/AMR med fokus på djur
29 GLOBAL UTBLICK
22,7 80 70 60 50 40 30 20 10 0 2001 2002 2003 2004 2005 2006 2007 2008 2009 2010 2011 2012 2013 2014 2015 2016 2017 2018 2019 2020 2021 25,7 26,2 29,6 33,5 36,6 40,6 42,3 42,4 44,1 46,5 48,7 52,7 55,1 57,3 59,4 61,4 62,2 64,1 62,3 64,7 66,8 11,0 11,2 12,3 12,6 13,2 14,0 14,5 14,2 15,0 15,0 16,4 16,3 17,1 18,0 18,6 20,2 21,7 23,4 19,7 14,6
Växtodling
I förorenade områden kan vatten som innehåller antibiotikarester och resistenta bakterier tas upp av vegetabiliska livsmedel genom bevattning. Dessutom gödslas ofta odlingsmark med gödsel som kan innehålla antibiotika från djur som medicinerats.
Animalieproduktion
Antibiotika används rutinmässigt i många länder för att förebygga sjukdom eller öka tillväxten hos livsmedelsproducerande djur. Antibiotika som använts på detta sätt kan nå människor via mjölkprodukter och kött och kan nå omgivningen via gödsel och avrinning från anläggningarna. Resistenta bakterier kan också utvecklas i djuren och spridas direkt till personer som sköter dem. Inom EU är det inte tillåtet att använda antibiotika i förebyggande syfte eller som tillväxtbefräm jande medel.
Internationellt resande
Antibiotikaresistenta bakterier tas upp av friska resenärer i ”högriskområden”. Dessa rese närer kan sedan sprida sådana resistenta bakteriestammar till helt nya områden.
Anläggningar som tillverkar läkemedel Fabriker som tillverkar antibiotika är viktiga källor för utsläpp av antibiotikarester i miljön. I synnerhet i Kina och Indien som producerar merparten av den antibiotika som används i världen. Skrämmande många fabriker släpper ut orenat eller bristfälligt renat avfall/ avloppsvatten i miljön.
Akvakultur
Fisk och skaldjur i djurtäta öppna anläggningar, i eller med direktkontakt med öppet vatten, behandlas ibland med antibiotika i förebyggande syfte (inte tillåtet i EU) eller vid sjukdomsutbrott. Behandlingen sker oftast via fodret som sprids direkt i vattnet och därmed i miljön.
Illustration ur Superbugs in the Supply Chain, changingmarkets.org 2016. Modifierad.

anläggningar, förebyggande sjukdomsutbrott. sprids
Sjukhus
Sjukhus är viktiga källor för uppkomst av antibiotikaresistenta bakterier eftersom de ständigt hyser många patienter som behandlas med olika typer av antibiotika. Stora mängder antibiotika och eventuella resistenta bakterier förekommer i avloppsvatten från sjukhus som ibland släpps ut direkt i vattendrag eller passerar reningsverk som inte kan rensa bort antibiotikarester.
Bostäder
Avföring och urin från personer som behandlas med antibiotika, innehåller rester av antibiotika och utgör en risk för utveckling av resistenta bakterier. I många länder går avloppen direkt ut i vattendrag och ned i grundvattnet utan någon form av rening.
Reningsverk
De flesta vattenreningsverk runt om i världen har inte kapacitet att filtrera bort antibiotika eller andra farmako logiska föroreningar, vilket innebär att rester av sådana substanser finns kvar i det vatten som lämnar renings verket. Avloppsreningsverk, där human avföring som innehåller en mängd bakterier blandas med vatten med rester av antibiotika utgör en idealisk miljö för uppkomst av antibiotikaresistens.

Källor till antibiotikaresistens
Antibiotika som släpps ut i miljön dödar känsliga bakterier, medan resistenta bakterier överlever. De senare kan sedan förökas och ibland överföra sin resistens till andra bakterier.
Antibiotikaresistens och antibiotikaanvändning i ett globalt perspektiv
Ulf Magnusson
Resistensutveckling mot antibiotika förekommer naturligt bland bakterier. Men utvecklingen går snabbare ju mer bakterierna exponeras för antibio tika. Det betyder att ju mer antibiotika vi använder, desto fler resistenta bakterier får vi. Det är därför angeläget att minska behovet av antibiotika och bara använda antibiotika när det verkligen är nödvändigt.

Antibiotikaanvändningen
Enligt samstämmiga uppgifter bedöms djurhåll ningen i världen använda omkring 70 procent av den totala mängden antimikrobiella mediciner1, alltså mer än dubbelt så mycket som inom hälsosektorn. Inom såväl djurhållningen som inom hälsosek torn finns globalt sett stora möjligheter att minska behovet av antibiotika genom sjukdomsförebyggande
åtgärder på det sätt vi gjort i Sverige. Inom hälso sektorn handlar det till exempel om förbättrad vat tenkvalitet, avlopp och sanitet i låg- och medelin komstländer och bättre vårdhygien generellt. Inom djurhållningen beskrivs de sjukdomsförebyggande åtgärderna vi framgångsrikt använt här i Sverige i detalj på annan plats i denna skrift. Runt om i värl den finns dock andra djurhållningssystem som gör exempelvis kontrollen av smittor svårare. Exempel på sådana system är nötkreatursuppfödningen i Nordamerika med omfattande transporter och blandning av djur från olika besättningar, noma diserande boskapsskötsel i Afrika och Asien, eller mindre besättningar av grisar och fjäderfä som har nära kontakt med vilda djur och fåglar.
Onödig eller överdriven antibiotikaanvändning för människor handlar – förutom när de används
bakterier (antibiotika).
Antibiotikaanvändning och antibiotikaresistens är dock mest relevant i ett One Health-perspektiv eftersom människor och djur kan infekteras av samma sorts bakterier och samma sorts antibiotika används på djur och människor.
Kungl. Skogs- och Lantbruksakademiens TIDSKRIFT nr
32
GLOBAL UTBLICK
5 2022
1. Antimikrobiella mediciner omfattar mediciner mot parasiter, svampinfektioner, virus och
Det nordamerikanska systemet för nötkreatursuppfödning, med omfattande transporter och blandning av besättningar, gör det svårt att kontrollera smittor. Foto: Bailey Alexander.
som en konsekvens av undermålig sanitet eller hygien enligt ovan – ofta om att virusinfektioner behandlas med antibiotika, något som är helt verk ningslöst. Att användningen är större inom djur hållningen globalt beror främst på att antibiotika används som tillväxtbefrämjare genom inblandning i foder, i regelmässigt sjukdomsförebyggande syfte och att hela grupper av djur behandlas. Detta förekommer inte inom hälsosektorn, men gemensamt är behandlingar utan riktiga laboratoriebaserade diagnoser – det vill säga att antibiotikan kan vara verkningslös mot infektionen i fråga. Den intensiva fjäderfä- och grisuppfödningen är de uppfödnings former där mest antibiotika används, vilket beror på oförmåga att tillämpa de sjukdomsförebyggande åtgärder som krävs för att hålla djuren friska utan regelmässig antibiotikatillförsel i dessa system. Man kan uttrycka det som att dålig djurhållning kom
penseras med regelmässig antibiotikaanvändning, vilket ibland är det ekonomiskt mest gynnsamma för producenten.
Tillgången till antibiotika varierar stort mellan och inom länder. Det förekommer också förfalskade mediciner i delar av världen. I låg- och medelin komstländer säljs en stor del av antibiotikan direkt från apotek eller i olika typer av affärer – utan in blandning av läkare eller veterinär. Detta ökar givet vis risken för felaktig och därmed onödig antibiotikaanvändning. I många länder, framför allt lågoch medelinkomstländer, kommer en betydande del av inkomsten för läkare och veterinärer från försälj ning av antibiotika. Detta gäller även för veterinärer i stora delar av EU, dock inte i de nordiska länderna (figur 1). Att läkare och veterinärer tjänar pengar på att sälja antibiotika bidrar inte till en återhållsam antibiotikaanvändning. a) b) c)
Figur 1.
Solid röd pil: distribution av antibiotika, tjockleken på pilen reflekterar andelen antibiotika som distribueras på detta sätt.
Streckad röd pil: diagnos utförd av/konsultation med veterinär.
Grå pil: förskrivning av antibiotika.
a) i ett land där antibiotika kan inköpas utan veterinärs recept och där djurhälsovården är dåligt utvecklad (oftast i låginkomstländer), b) i ett land där antibiotika inte kan inköpas utan recept, men där veterinären är tillåten att sälja antibiotika direkt till djurhållaren (vanligt i medel- och höginkomstländer), c) i ett land där antibiotika inte kan inköpas utan recept och där veterinären inte är tillåten att sälja antibiotika direkt till djurhållaren (i några höginkomstländer).

Källa: Magnusson et al. 2021. Rev Sci Tech. doi:10.20506/rst.40.2.3241 (med tillåtelse att reproducera).
Miraklet som skapat ett monster – antibiotikaresistens/AMR med fokus på djur
33 GLOBAL UTBLICK
Tre olika sätt att distribuera antibiotika till en djurhållare:
Antalet länder med förbud mot att använda antibiotika som tillskott i foder ökar ständigt enligt WOAH (tidigare OIE). Globalt finns ingen officiell statistik över antibiotikaanvändningen inom djur hållningen, till skillnad mot den europeiska läkeme delsmyndighetens årliga och detaljerade rapporter: European Surveillance of Veterinary Antimicrobial Consumption (ESVAC) Annual Reports. De mest omfattande, och oftast citerade, vetenskapliga rap porterna om ”antimicrobial consumption” inom djur hållningen, gör gällande att totalt sett används mest antibiotika i de stora livsmedelsproducerande län derna Kina, Brasilien och USA och där står Kina för nästan hälften av världens användning av antimikrobiella läkemedel inom djurhållningen (figur 2).

Slutligen ska det poängteras att antibiotika och andra mediciner behövs inom djurhållningen för att behandla sjuka djur; att underlåta behandling är oacceptabelt av etiska skäl. Alternativet, att avliva
dessa djur för destruktion, är ett stötande slöseri med naturresurser och leder till negativ miljöpåverkan.
Resistens
Om det är svårt att få en samlad och rättvisande bild av antibiotikaanvändningen i världen, är det ännu svårare att få en sådan bild av antibiotikaresistensen. Inom EU finns övervakningsprogram för förekomsten av resistenta bakterier. Vissa av dessa är specifika för människor respektive djur, medan andra är gemensamma. Dessutom finns en rad natio nella program, varav Sveriges är bland de äldsta och mest utvecklade. Sammantaget visar dessa program att förekomsten av antibiotikaresistenta bakterier i Sverige är bland de lägsta inom EU.
Globalt finns inga systematiska, eller gemen samma, program för övervakning av antibiotikaresistens. Vår samlade kunskap baseras i stället på en
Figur 2. Användning av antimikrobiella läkemedel per land 2017 och 2030. Storleken på cirklarna motsvarar mängden använda antimikrobiella läkemedel. Mörkröda cirklar motsvarar mängderna använda 2017, och den yttre blå ringen motsvarar den beräk nade ökade användningen 2030. (Tiseo et al 2020. Antibiotics. doi:10.3390/antibiotics9120918, bilden reproducerad med tillåtelse enligt CC BY 4.0-licens).
Kungl. Skogs- och Lantbruksakademiens TIDSKRIFT nr 5 2022
34
GLOBAL UTBLICK
50 000 ton 10 000 ton 2 000 ton 500 ton 2030 2017
mångfald av vetenskapliga rapporter där olika me toder och tillvägagångsätt använts. Försök har gjorts att balansera sådana rapporter för djurhållningen från låg- och medelinkomstländer. Dessa visar bety dande skillnader mellan olika delar av världen, men en sådan analys är starkt beroende av tillgången till vetenskapliga data.
Generellt är resistensläget avsevärt sämre i lågoch medelinkomstländer jämfört med Sverige. Det handlar om antalet antibiotika som man hittar resistens emot, förekomsten av resistens mot antibiotika som är synnerligen kritiska för humanmedicinen, förekomsten av multiresistenta bakterier och före komsten av antibiotikaresistens över huvud taget. Detta gäller såväl inom djurhållningen som inom hälsosektorn.
Vägen framåt…
I ett globalt perspektiv är minskad användning av antibiotika inom djurhållningen avgörande för att
reducera utveckling och spridning av antibiotika resistens. Således är det angeläget att antibiotika endast används när det verkligen behövs. Det kan behövas såväl regulatoriska ingripanden som eko nomiska incitament för att åstadkomma en sådan medicinsk rationell antibiotikaanvändning. De po sitiva incitamenten är särskilt viktiga där kapaciteten för att kontrollera efterlevnaden av regelverk är svag. Följande åtgärder är centrala för att åstadkomma ett minskat och mer medicinskt rationellt användande av antibiotika:
• Djursjukvård finns tillgänglig för djurhållare till rimligt pris.
• Antibiotika säljs endast på recept från veterinär.
• Veterinärer tjänar inte pengar på att sälja eller förskriva antibiotika.
• Veterinärer har goda kunskaper i sjukdomsföre byggande åtgärder – vaccinologi, smittskydd, etc.
• Fördelarna med sjukdomsförebyggande åtgärder är så stora att djurhållare är villiga att betala för dem.
Rekommenderad läsning
FAO. 2020. Tackling antimicrobial use and resistance in dairy cattle: Lessons learned in Sweden. Rome. https://doi.org/10.4060/cb2201en
European Medicines Agency, 2021. Sales of veterinary antimicrobial agents in 31 European countries in 2019 and 2020. 11th ESVAC report. https://www.ema.europa.eu/en/documents/report/sales-veterinary-antimicrobial-agents-31-european-countries-2019-2020-trends2010-2020-eleventh_en.pdf
Magnusson U, Moodley A, Osbjer K. 2021. Antimicrobial resistance at the livestock-human interface: implications for Veterinary Services. Rev Sci Tech. 2021 Aug;40(2):511–521. English. https://doi.10.20506/rst.40.2.3241
OIE, 2021. OIE Annual Report on Antimicrobial Agents Intended for Use in Animals. 5th Report. https://www.oie.int/app/uploads/2021/05/a-fifth-annual-report-amr.pdf
Tiseo K, Huber L, Gilbert M, Robinson TP, Van Boeckel TP. 2020. Global Trends in Antimicrobial Use in Food Animals from 2017 to 2030. Antibiotics. 2020; 9(12):918. https://doi.org/10.3390/antibiotics9120918
Miraklet som skapat ett monster – antibiotikaresistens/AMR med fokus på djur
35 GLOBAL UTBLICK
Antimicrobial use in low-income countries –with examples from Uganda
Justine Alinaitwe
Increased demand for livestock products in developing countries has resulted in intensification of agri culture with subsequent increase in antimicrobial agents used in livestock. In low-income countries, livestock production systems are generally charac terized by excessive use and misuse of unprescribed antibiotics as growth promoters, feed additives and means of disease prevention. The limited access to af fordable diagnostic laboratories drives the prolonged use of antibiotics since various classes of antimicro bials often are used ”in tandem” for treatment. This is particularly true for chronic infections and even when the antibiotics are prescribed by veterinarians. The problem is further complicated by lack of knowledge on the impact of misuse of antimicrobials and weak regulatory framework to track anti microbial use and resistance patterns. Overuse of antibiotics in food animals is a multi-faceted problem impacting directly on food safety by increasing drug residues in livestock products but also facili tates genetic mutation of bacteria increasing occur rence of drug resistant pathogens. This ultimately has a negative impact on efficacy of veterinary medi cines on the market. Furthermore, indiscriminate disposal of animal waste from such animals inevita bly contaminates the environment and ground water sources with such pathogens, some of which cause severe disease in animals and humans (Byarugaba et al. 2011).
Regulation of AMU in Uganda
Regulation and control of all drugs is a preserve for the National Drug Authority which is mandated to inspect, register and regulate both human and veterinary drugs in the country in accordance with the national drug policy of 1993. Even though veteri nary surgeons are the only personnel with the legal authority to prescribe antibiotics, there are a number of people who privately run drug stores and prescribe
antibiotics indiscreetly; including paraveterinarians, farm managers and farmers. There are a number of sufficient laws and policies regulating antibiotic use in the country, except they are not effectively imple mented due to fiscal challenges and lack of enough personnel on ground to enforce regulations.
Veterinary Services in Uganda
In Uganda, veterinary services were decentralized and privatized in 1991 due to fiscal challenges in the public sector at the time; implying that farmers who cannot afford the service opt to treat their own ani mals without relevant technical advice, often con sulting each other instead. Veterinary clinical services, livestock breeding and vector control activities were privatized while the Ministry of Agriculture, Animal Industries and Fisheries (MAAIF) retained critical services such as mass vaccination against notifiable epidemic diseases with periodic supply of free vaccines when outbreaks occur.
As a result, there are many private actors involved in providing various animal health services, however, these are unregulated and often unsupervised since the services are not streamlined. Factors such as poor animal husbandry practices, insufficient disease prevention measures with high disease in cidence, have been listed as main drivers for overuse of antibiotics in food animals in Uganda due to limited extension services. With antimicrobials of choice freely accessible over the counter without prescription, farmers can purchase any class of drug and administer to their animals at will (Ilukor, et al., 2012). In 2015, the Global Antibiotic Resistance Partnership (GARP)-Uganda, reported 18.4 percent hospital-based mortality due to pneumonia, tuber culosis and sepsis. Among some of these bacteria, antimicrobial resistance was as high as 80 percent (UNAS, 2015).
Kungl. Skogs- och Lantbruksakademiens TIDSKRIFT
36
nr 5 2022 GLOBAL UTBLICK
Government Efforts to Address Antimicrobial Resistance
In response to the above reports, the Government of Uganda set up a laboratory network established at the Central Public Health Laboratory to carry out sur veillance for major enteric pathogens and map their antibiotic resistance patterns. In addition, in 2017, Uganda adopted a One Health approach which includes the human, animal, agriculture, and environ mental sectors in developing the National Action Plan (NAP) to address issues concerning antimi crobial resistance across the country. A consortium headed by the Infectious Diseases Institute com prising the departments of Pharmacy, Veterinary Medicine and Microbiology at Makerere University, secured funding from the Fleming Fund and was formed in 2018 to conduct active surveillance on AMR and make strategic plans to intervene. Policies have been drafted to guide rationale use of antimi crobials in Uganda; however, with limited systematic surveillance, and active monitoring for antimicrobial use, it is difficult to implement such guidelines.
SLU Support on AMR/U in Uganda
In 2020, The Livestock Health flagship under the CGIAR Research Program on Livestock in part
nership with SLU together with colleagues from Makerere University, Ministry of Agriculture, Animal Industries and Fisheries (MAAIF) and District Local Governments in Uganda conducted a series of trainings in Uganda to improve livestock health, maintaining high livestock productivity with low use of antibiotics. The Livestock CRP provided research-based solutions to help smallholder farmers, pastoralists and agro-pastoralists transition to sustainable, resilient livelihoods and productive sys tems. The trainings intended to draw on Sweden’s long-term experience in producing healthy and pro ductive animals with low antibiotic use. By combining lecturing with exercises using practical examples from Sweden and Uganda, providing participants with hands-on skills on judicious use of antibiotics, without endangering animal health, welfare, and productivity.
Due to travel restrictions following the Covidpandemic, the training was organized in a hybrid format where the participants were meeting on-site together with Ugandan trainers and SLU colleagues were remotely participating on-line and by pre-recor ded presentations. Through these participatory train ing sessions, 143 key animal health professionals, veterinary drug suppliers, policy makers and farmers were trained on improving livestock productivity

37 GLOBAL UTBLICK
Miraklet som skapat ett monster – antibiotikaresistens/AMR med fokus på djur
A training session for animal health professionals. Photo: Justine Alinaitwe.
with low use of antibiotics, emphasizing mainly on herd health strategies in three districts in the coun try: Kampala, Masaka and Mukono. Unlike most trainings, after these sessions, participants were fol lowed up in the field to provide continuous technical support to aid implementation of agreed interven tions in the field. Community sensitization trainings were also conducted to further create awareness on antimicrobial resistance and its impact on human health.
Through a participatory appraisal session, the project identified lack of information, poor hus bandry practices, limited access to extension services and poor record keeping among farmers as the major challenges hindering production and driving over-use of antibiotics in pig farming. Interventions implemented with a selected number of participants included routine vaccination and regular deworm-
ing, improving biosecurity, sanitizing farm wear, and batchwise segregation and management of pigs on farm.
Trained farmers were organized into a WhatsApp group through which information is readily provi ded on demand and disease outbreaks reported for prompt action. In addition, herd health management manuals were produced to guide farmers on good agricultural practices and biosecurity along with re cord keepings booklets to improve management. An animal health professionals guide was also produced and disseminated after the training to provide guidance on disease diagnosis in the field and prudent use of antimicrobials.
Significant changes were registered among the trained participants, 12 farmers were monitored on farm for a period of 6 months with visible improve ment in animal health and improved weight gain.
Kungl. Skogs- och Lantbruksakademiens

38
TIDSKRIFT nr 5 2022 GLOBAL UTBLICK
Local field training session on AMR. Photo: Justine Alinaitwe.
Local Government animal health professionals trained have incorporated AMR into the routine farmer trainings conducted on a quarterly basis for sustainability. In conclusion, provision of vital infor mation to the relevant stakeholders through training with continuous extension services can improve live stock productivity while reducing the need for anti
microbials in food animals, thus ultimately contributing to the fight against antimicrobial resistance. This training package – Productive Livestock with Low Use of Antibiotics – is now freely available from the SLU web-site for anyone, individual or institu tion, to run the training on fighting AMR in the livestock sector in low-income countries.
References
Alinaitwe J, Osbjer K, Ikwap K, Lubega S , and Magnusson U. 2021. Productive Livestock with Low Use of Antibiotics, https://slu-se. instructure.com/courses/5562
Ilukor J, Birner I, Rwamigisa P, and Nantima N. 2012. Analysis of veterinary service delivery in Uganda: An application of the process net-map tool. September 2012, Conference: Tropentag conference: Resilience of agricultural systems against crises. Gottingen –Kassel/Witzenhausen.
Magnusson, U. 2021. How to use antibiotics effectively and responsibly in pig production for the sake of human and animal health. Budapest, FAO. https://www.fao.org/documents/card/en/c/cb4158en
Osbjer, K. and Magnusson, U. 2021. Promoting medically rational and responsible use of antimicrobials for healthy and productive livestock. Policy Brief. Nairobi, Kenya: ILRI. https://hdl.handle.net/10568/116140
UNAS, CDDEP, GARP-Uganda, Mpairwe, Y., & Wamala, S. 2015. Antibiotic Resistance in Uganda: Situation Analysis and Recommendations (pp. 107). Kampala, Uganda: Uganda National Academy of Sciences; Center for Disease.
Miraklet som skapat ett monster – antibiotikaresistens/AMR med fokus på djur
39 GLOBAL UTBLICK
Förbättrad EU-lagstiftning – kommer den att fungera?
 Jenny Lundström
Jenny Lundström
År 2022 inleddes med stort fokus på antibiotikare sistens. I en artikel i The Lancet konstaterades det att antibiotikaresistens orsakade 1,27 miljoner dödsfall i världen år 2019 och att tidigare bedömningar är grava underskattningar.1 Inom EU gäller från den 28 januari en ny strängare lagstiftning för läkeme del till djur. I de nya reglerna ingår bland annat att antibiotika inte längre får ges rutinmässigt till friska djur och att transparensen kring antibiotikaanvänd ning måste öka. Just då det gäller transparens har även viktiga förbättringar införts i Sverige genom den proposition som riksdagen fattade beslut om i november 2021.
Ny EU-lagstiftning i nivå med svensk praxis för antibiotikaanvändning För veterinärer och lantbrukare verksamma i Sverige innehåller den nya lagstiftningen sådant som under lång tid betraktats som självklarheter. 2 Antibiotika får inte användas rutinmässigt eller för att kompen sera för dålig hygien och skötsel, och förebyggande behandling (profylax) är bara tillåtet i undantagsfall och då bara till enskilda djur.
Behandling av grupper av djur (metafylax), där en del individer, men inte alla, visar sjukdomssymp tom får endast ske när risken för spridning av smit tan är stor och då andra lämpliga alternativ saknas. All antibiotikaanvändning omfattas av krav på ve terinär förskrivning, och recept för antibiotika kom mer bara att ha en giltighetstid på fem dagar (vilket är en skärpning även ur svenskt perspektiv).
Kommer regelverket att följas?
Den senaste statistiken över antibiotikaförsälj ning från the European Surveillance of Veterinary Antimicrobial Consumption (ESVAC)3 för år 2020 visar dock att en stor andel av den antibiotika som användes var för gruppbehandling. Snittet för samt

liga 31 länder som ingår i redovisningen var att 87 procent av försäljningen var för gruppbehandling. I Sverige var den andelen mindre än 10 procent. Resultatet indikerar att antibiotika fortfarande an vänds på ett rutinmässigt sätt för att kompensera för dålig hygien och skötsel inom stora delar av EU. Många djurhållare inom EU står alltså inför en liknande situation som den som svenska bönder och veterinärer fick tackla 1986, då Sverige förbjöd an vändning av antibiotika som fodertillsats i tillväxt främjande syfte. Efter förbudet ökade den veterinära förskrivningen eftersom sjukligheten under vissa riskperioder (till exempel avvänjningsperioden för gris) ökade. Det ledde till ett intensivt samarbete mellan lantbrukare, veterinärer och statliga myn digheter för en förbättrad djurhållning och kom petensutveckling, men det tog ändå ända till 1995 innan den veterinära förskrivningen av antibiotika låg under nivån innan förbudet kom.4
Kungl. Skogs- och Lantbruksakademiens TIDSKRIFT nr
40
GLOBAL UTBLICK
5 2022
En strängare EU-lag från den 28 januari ställer djurhållare inom EU inför samma situation som den som svenska bönder och veterinärer hade 1986, då Sverige förbjöd användning av antibiotika som foder tillsats i tillväxtfrämjande syfte. Foto: Parv2fast, CC BY-SA 4.0.
Förändringsresan inom EU borde alltså ha på börjats för länge sen, och statistiken från 2020 reser frågor om hur långt man har kommit. Farhågor har också lyfts i en rapport skriven för European Public Health Alliance.5 Man anser att det är stor risk för bristande efterlevnad av den nya lagstiftningen, eftersom djuruppfödningen i många länder fortfa rande bedrivs på sätt som medför stora risker för djurhälsan.
Ökad transparens i statistiken – en viktig drivkraft för förbättringsarbetet
Att få fram en gemensam och myndighetsbase rad statistik över försäljningen av antibiotika inom EU-/EES-området har varit avgörande för det för ändringsarbete som ändå har gjorts för att minska antibiotikaanvändningen. De flesta länder, dock inte alla, som ingår i statistiken visar på minskande trend, och för de 25 länder som levererat statistik samtliga år mellan 2011 och 2020 har den genom snittliga användningen minskat med 43 procent.
Inom några år kommer också transparensen att öka, då statistiken kommer att bli uppdelad djurslagsvis. År 2024 kommer djurslagsvisa data att re dovisas för gris, nötkreatur (med specifikt fokus på nötkreatur upp till 1 år), kyckling och kalkon. För övriga livsmedelsproducerande djur införs djurslags visa data i rapporten 2027.
Redan idag kan ett antal EU-länder få fram djurslagsvisa data, och ett av de länder som kom mit väldigt långt i det arbetet är Nederländerna. År
2010 bildades en särskild myndighet, Netherlands Veterinary Medicines Institute (SDa), för att främja ansvarsfull läkemedelsanvändning inom den nederländska djurhållningssektorn. En rapport över anti biotikaanvändningen publiceras årligen6 , och statis tiken är inte bara uppdelad på djurslag utan även på uppfödningsform, som till exempel suggor med smågrisar respektive slaktsvin. Rapporten innehåller också ett jämförande avsnitt, som redovisar sprid ning i användningen mellan gårdar. Data är givetvis anonymiserade, men som lantbrukare vet man sina egna data och kan se var man ligger i spannet mellan dem som förbrukar mycket och dem som förbrukar lite. Det finns också tröskelvärden för när åtgärder bör vidtas. På liknande sätt redovisas även data för veterinärkårens förskrivning. Spridningen i båda grupperna är betydande, vilket innebär att det finns stora möjligheter till förbättringsarbete.

Förbättrade uppföljningssystem även i Sverige Sverige är det land som år efter år i ESVAC:s rap porter haft den lägsta antibiotikaanvändningen av alla länder inom EU. Samtidigt har vi inte legat i topp när det gäller transparenta och djurslagsuppdelade data, vilket har försvårat både för veterinärer nas egna uppföljningar samt myndigheternas tillsyn av veterinärer. Men nu är det på gång. Riksdagen beslutade 25 november 2021 att bifalla regeringens proposition ”Bättre uppföljning av läkemedel för djur” (Prop. 2020/21:220).7 De ändringar som nu
Miraklet som skapat ett monster – antibiotikaresistens/AMR med fokus på djur
41 GLOBAL UTBLICK
Ett land som kommit långt i arbetet med djurslagsvisa data är Nederländerna, bland annat tack vare myndigheten Netherlands Veterinary Medicines Institute. Frigående höns i den holländska byn Barneveld. Foto: Rasbak, CC BY-SA 3.0.
gjorts i lagstiftningen, som trädde i kraft 1 januari 2022, innebär att samtliga uppgifter som anges vid f örskrivning av lä kemedel f ör behandling av djur ska delges till E-hä lsomyndigheten från apoteken. Därigenom blir statistiken mycket mer tillförlitlig och detaljerad vilket ger förbättrade möjligheter till uppföljning och kontroll.
Antibiotikafrågan fortsatt i ropet
Antibiotikaresistens bedöms av många som vår nästa pandemi8 , och den spridning som artikeln i The Lancet fått visar att frågan berör.1 Fortfarande
används mer antibiotika till djur än till människor och fortfarande är en stor del av användningen inom djursektorn, globalt sett, för icke-terapeutiska syf ten. Att använda ett värdefullt läkemedel som ett rutinmässigt insatsmedel för ökad djurproduktion kommer bli alltmer ifrågasatt. De steg som nu tas inom EU, med striktare regler och ökad transpa rens, är viktiga men de måste också kombineras med insatser för en förbättrad djurhållning och kravstäl lande från handeln. De lantbrukare som vidtar åt gärder för en förbättrad djurhållning måste känna sig trygga med att de inte tappar marknadsandelar under omställningsfasen.
Referenser
1. https://www.thelancet.com/journals/lancet/article/PIIS0140-6736(21)02724-0/fulltext
2. https://www.lakemedelsverket.se/sv/nyheter/nya-regler-for-lakemedel-till-djur-borjar-galla-idag
3. https://www.ema.europa.eu/en/documents/report/sales-veterinary-antimicrobial-agents-31-european-countries-2019-2020-trends2010-2020-eleventh_en.pdf
4. https://www.sva.se/media/8d967af89d0bba2/faktablad-antibiotikaförsäljning-sverige.pdf
5. https://epha.org/wp-content/uploads/2022/02/report-ending-routine-farm-antibiotic-use-in-europe-final-2022.pdf
6. https://cdn.i-pulse.nl/autoriteitdiergeneesmiddelen/userfiles/sda%20jaarrapporten%20ab-gebruik/ab-rapport-2021/uk-sda-report-usage-ofantibiotics-in-agricultural-livestock-in-nl-2021.pdf
7. https://www.regeringen.se/rattsliga-dokument/proposition/2021/09/prop.-202021220/
8. https://www.reactgroup.org/news-and-views/news-and-opinions/year-2021/preventing-the-next-pandemic-addressing-antibiotic-resistance/
Kungl. Skogs- och Lantbruksakademiens TIDSKRIFT nr 5 2022
42
GLOBAL UTBLICK
Så blev Sverige ett föregångsland
Antibiotika kan användas i terapeutiska doser för att bota eller lindra sjukdomssymptom (terapeutisk användning) eller för att förebygga sjukdom (före byggande användning eller profylax). För båda än damålen kan antibiotika administreras antingen till enskilda djur eller grupper av djur. När antibiotika ges till en grupp djur efter att en klinisk sjukdoms diagnos har fastställts i delar av den gruppen, kan termen ”metafylax” användas. Syftet med metafy lax är att behandla kliniskt sjuka djur i en grupp samtidigt som man förhindrar spridning till andra djur i gruppen. Antibiotika kan också användas som tillväxtbefrämjare när de administreras i lägre (sub terapeutiska) doser. Syftet med sådan användning är att öka tillväxten eller avkastningen.
Den svenska modellen och antibiotikan Svensk djurhållning kännetecknas sedan många år av ett holistiskt synsätt. Förebyggande djurhälsoarbete, såsom utrotande av infektionssjukdomar, införande av hygienåtgärder och avel med fokus på djurhälsa, i kombination med hälsosamma djurmil jöer, inklusive ett gott djurskydd, gör att djuren hålls friska och behovet av antibiotika är lågt.
Svensk veterinärmedicin har en stark tradition av förebyggande djurhälsoarbete. Systematiska an strängningar att utrota bovin tuberkulos började på 1930-talet och smittan försvann från landet på 1950-talet. Detta följdes av andra insatser för att kontrollera eller utrota smittsamma sjukdomar hos produktionsdjur, inklusive salmonella, Aujeszky’s sjukdom hos grisar och bovin virusdiarré hos nöt kreatur. I mitten av 1900-talet intensifierades och specialiserades animalieproduktionen i många höginkomstländer. Även om utvecklingen var mer blyg sam i Sverige infördes nya djurhållningssystem och produktionssjukdomar uppstod snart i dessa nya in tensiva system. Förebyggande strategier blev allt vik tigare och svensk forskning fokuserade på att förebygga produktionssjukdomar. Parallellt utvecklades den förebyggande djurhälsovården med statligt stöd.
Systemet, som kännetecknas av ett nära samarbete mellan olika aktörer, har upprätthållits genom åren (se Lena Eliasson-Sellings artikel på sidan 46). Samtidigt började tanken att tekniken skulle an passas till djuren, snarare än tvärtom, få fotfäste i Sverige och sedan början av 1970-talet har det varit obligatoriskt med förprövning av nya djurstallar för att säkerställa att de följer djurskyddslagstiftningen. Penicillinets upptäckt och användningsområ den belystes i Svensk Veterinärtidskrift redan 1945 och penicillin blev snart ett terapeutiskt verktyg för svenska veterinärer. Några år senare rapporterade en artikel i samma tidskrift att penicillin hade revolu tionerat behandlingen av bland annat juverinflam mation (mastit). Författaren efterlyste insatser för att övertyga svenska veterinärer att använda det nya läkemedlet, men rekommenderade också att käns lighetstestning skulle genomföras i syfte att undvika onödig användning av antibiotika. År 1950 blev det obligatoriskt för jordbrukare att anmäla antibiotikabehandling av nötkreatur till mejerierna. Syftet var att begränsa förekomsten av antibiotikarester i mjölken då dessa kan påverka mejeriproduktionen negativt. Vidare angavs att veterinärer inte skulle lämna ut antibiotika utan föregående klinisk under sökning. Detta visar att en viss medvetenhet om re sistens kopplat till användning av antibiotika fanns redan vid den tidpunkten. Detta är ännu tydligare i Lantbruksstyrelsens kungörelse från 1979, där det anges att läkemedel för användning till djur bör förskrivas med stor återhållsamhet och endast när behov föreligger.
Penicillin blev snabbt ett terapeu tiskt verktyg för veterinärer.
Foto: Owen Massey McKnight, CC BY-SA 2.0 .
Miraklet som skapat ett monster – antibiotikaresistens/AMR med fokus på djur

43 FÖREGÅNGSLANDET SVERIGE
Kristina Nordéus
Förbudet mot tillväxtbefrämjande antibiotika

Vid den tiden omfattades antibiotiska läkemedel av läkemedelslagstiftningen medan antibiotika som fodertillsats (för användning i låga eller höga doser) omfattades av foderlagstiftningen. Foder som innehöll låga doser av antibiotika (tillväxtbefrämjare) kunde köpas fritt, medan foder som innehöll höga doser (för terapeutisk eller förebyggande användning) måste förskrivas av veterinär. Tillväxtbefrämjare betraktades huvudsakligen som ett tekniskt hjälpmedel. I slutet av 1970-talet och början av 1980-talet skärptes reglerna – kraven för godkän nande stärktes och ett antal substanser plockades bort ur arsenalen. Några av de inblandade statliga myndigheterna uttryckte oro över användningen av tillväxtbefrämjare, men den övergripande stånd punkten var att tillväxtbefrämjare fortsatt kunde hanteras i foderlagstiftningen och att användningen kunde fortsätta. Användningen ökade och tillväxt befrämjare tillfördes rutinmässigt nästan allt foder för grisar och slaktkycklingar. En artikelserie i DN i början av 1980-talet uppmärksammade och kri tiserade det moderna jordbruket, inte minst den ”industrialiserade” djurhållningen där ”kemikalier” användes f ör att motverka negativa effekter av dåliga djurmiljöer och för att få djuren att växa snabbare. I artiklarna nämndes också risken för antibiotikaresistens kopplat till sådan användning. Det bör dock noteras att huvudsakligt fokus i debatten inte låg på risken för antibiotikaresistens utan snarare på att livsmedelsproducerande djur i stor utsträckning fick ”kemikalier” i sitt foder.
Den inhemska jordbruksmarknaden var hårt reglerad med fasta priser för flera jordbruksproduk ter och produktionskooperativ under LRF:s paraply dominerade marknaden. Av oro för minskat konsu mentförtroende på grund av den negativa diskursen antog LRF 1981 en antibiotikapolicy som angav att man ville verka för en begränsad och väl kontrol lerad användning av antibiotika i svensk djurhåll ning. Endast godkända ämnen skulle användas och användningen skulle ske på ett säkert sätt och med hänsyn till folkhälsan. Vidare efterlyste man forskning om förebyggande djurhälsoåtgärder och underströk vikten av sunda djurmiljöer. År 1984 be slutade LRF:s stämma att man skulle verka för ett förbud mot tillväxtbefrämjare. Det lades även fram riksdagsmotioner i frågan. Vid den tiden pågick en långdragen översyn av foderlagstiftningen. Det ur sprungliga underlaget till den nya lagen innehöll inte något förslag till förbud, men den lag som antogs 1985 slog fast att antibiotika endast fick användas på djur för att bota, förebygga eller lindra sjukdoms symtom. Lagen, som trädde i kraft i januari 1986, innebar i praktiken ett förbud mot tillväxtbefräm jande antibiotika.
Lyckad övergång trots stora utmaningar Redan före förbudet hade man i stor utsträckning frångått användning av tillväxtbefrämjare till kalvar eftersom sådan användning hade begränsad nytta. Förbudet hade därför liten eller ingen effekt på produktionen eller djurhälsan i nötsektorn. Slaktkycklings- och smågrisuppfödare drabba des desto hårdare. I slaktkycklingsuppfödningen
Kungl. Skogs- och Lantbruksakademiens TIDSKRIFT
44
nr 5 2022 FÖREGÅNGSLANDET SVERIGE
Förbudet hade liten effekt på nötsektorn eftersom man redan i stor utsträckning frångått användning av tillväxtbefrämjare till kalvar Foto: Per Eriksson.
användes lågdosantibiotika främst för att förhindra allvarlig tarmsjukdom (nekrotiserande enterit) orsa kad av bakterien Clostridium perfringens. Näringen insåg därför inte inledningsvis att förbudet gällde dem. När det stod klart att näringen stod inför en stor utmaning arbetade man tillsammans med be rörda myndigheter och akademin för att klara om ställningen. Under tiden rekommenderades veteri närer att skriva ut samma antibiotika, men i högre doser, till flockar med hög risk för sjukdomsutbrott. Under de följande två åren upphörde den rutinmäs siga användningen av antibiotika. Med förbättrade djurmiljöer och skötselrutiner samt nya foder kunde omställningen ske utan märkbara effekter på pro duktionen eller djurhälsan. Introduktionen av jonofor koccidiostatika spelade troligen en avgörande roll i den lyckade övergången tack var den förebyg gande effekten på nekrotisk enterit.


Inom grissektorn hade de negativa effekterna av att ta bort tillväxtbefrämjare till smågrisar under skattats. Utan tillsats av antibiotika var tillgängligt foder olämpligt för smågrisar vid övergång från mjölk till fast foder. Dessutom var många gris stallar gamla och ohygieniska, vilket ytterligare ökade risken för utbrott av infektionssjukdomar. Grisnäringen drabbades hårt av djurhälsoproblem och sviktande produktion, främst orsakat av avvänj ningsdiarré. Förbättrade djurmiljöer, foder samt
hygien- och skötselrutiner vände långsamt den negativa trenden. Särskilt viktigt var införandet av omgångsuppfödning och sektionering av grisstallar, samt användning av zinkoxid för att förhindra av vänjningsdiarré. Inledningsvis ledde förbudet till en ökad användning av antibiotika till följd av de ökade djurhälsoproblemen. Vissa av de tillväxtbefrämjande substanserna listades också som läkemedel och bör jade användas i högre doser.
Svensk djurhållning förändrades i grunden Förbudet mot tillväxtbefrämjare och de diskussioner som följde förbudet utlöste en process som i grunden förändrade svensk djurhållning. Detta förstärktes genom den nya långtgående djurskyddslagen som antogs 1988. Under parollen ”Friska djur behöver inte antibiotika” har fokus för svenskt arbete mot antibiotikaresistens inom djurhållningen sedan dess legat på att förbättra djurhälsan, snarare än att mins ka användningen av antibiotika, och arbetet har gett effekt. Den svenska f örsäljningen av antibiotika till djur har minskat kontinuerligt sedan 1992 och är nu den lägsta i EU. Sverige kom också att spela en viktig roll i processen som ledde till EU-förbudet mot tillväxtbefrämjande antibiotika, men det är en annan historia.
De negativa effekterna av att ta bort antibiotika som tillväxtbe främjare till smågrisar som skulle avvänjas hade underskattats. Åtgärder av olika typer, med sikte på bättre djurmiljöer, har dock gjort att behovet minskat även här. Foto: benj500, CC0.
Miraklet som skapat ett monster – antibiotikaresistens/AMR med fokus på djur
45 FÖREGÅNGSLANDET SVERIGE
Bakterien Clostridium perfringens orsakar nekrotiserande enterit, en allvarlig tarmsjukdom som förekommer hos fjäderfä.
Foto: Andreas Zautner, Public domain.
Så arbetar vi idag i Sverige mot antibiotikaresistens i grisuppfödningen
Inledning
Vilka erfarenheter inom svensk grisproduktion kan vara av internationellt intresse?
I Sverige föds cirka 2,5 miljoner grisar upp till slakt varje år. Det är en bråkdel jämfört med Danmark och Tyskland där det varje år slaktas 20 respektive 58 miljoner grisar. I ett globalt perspek tiv är målet med animalieproduktionen främst att producera livsmedel till ett lågt pris och förebygga hunger. I Sverige tillsammans med många i-länder finns ekonomiskt utrymme för att även fokusera på djurskydd och djurhälsa. Ett gemensamt globalt mål är att använda antibiotika på ett klokt sätt så att ut veckling av resistens mot antibiotika förebyggs.
Förklaringen till dagens internationella intresse för svensk grisproduktion är att Sverige idag föder upp grisar på ett effektivt och rationellt sätt och med bibehållen låg antibiotikaförbrukning och bibehål len djurvälfärd. Ett mått på de sistnämnda är att alla grisar föds upp med knorr på svansen.
Följande strategier tillämpas för att uppnå en hög hälsostatus och för att motverka uppkomst av anti biotikaresistens (AMR) i svenska grisbesättningar:
1. Förbud sedan 1986 mot rutinmässig användning av antibiotika.
2. Sjukdomsförebyggande åtgärder i form av orga niserad hälsokontroll, planerad och ålderssek tionerad produktion med smittskyddsbarriärer såväl inom besättning som mot omvärlden är idag legio i landets grisbesättningar. Häri ingår även att vaccinera mot identifierade endemiska bakteriella sjukdomar för att upprätthålla en hög hälsa och därmed även minska antibiotikakon sumtionen.
3. Klok användning av antibiotika genom att ha ru tinmässiga veterinärbesök och skriftliga rutiner för hur antibiotika ska användas på besättnings nivå. De kliniska iakttagelserna av sjukdomar kompletteras med regelbunden diagnostik med
hjälp av laboratorieanalyser och/eller obduktio ner för att identifiera såväl bakteriella sjukdomar som resistensläget för dessa.
Rutinmässig användning av antibiotika förbjöds 1986 Redan på 1960-talet började diskussionen om faran av antibiotikaresistens (AMR) hos lantbrukets djur, de första studierna gjordes på kalvar och sedermera på gris. Undersökningar gjordes i samar bete mellan näringens och akademins (Kungliga Veterinärhögskolan) veterinärer. Samarbetet har därefter fortsatt mellan näringens veterinärer, officiella veterinärer och forskare på SLU/SVA. Övervakningsprogrammet Swarmpat är ett bra exempel på hur samarbetet utvecklats.1 Hur Sverige histo riskt har arbetat mot AMR inom svensk animalie produktion finns väl dokumenterat. 2
Motionen som ledde till att förbudet mot till växtbefrämjande substanser infördes 1986 utgick från Lantbrukarnas Riksförbund (LRF). De till växtbefrämjande substanser som användes var låga doser av antibiotika som blandades i fodret (lågdosantibiotika).
Det utkristalliserades snabbt vilka besättningar som hade bra eller dålig smågrishälsa och det upp stod ganska snart regionala skillnader i den veterinä ra förskrivningen och därmed också i användningen av antibiotika som blandades i fodret – ”foderanti biotika”. Detta ledde till att husdjurssektionen inom Sveriges veterinärmedicinska sällskap (SVS) redan 1990 formulerade den policy för gruppbehandling av djur med antibiotika som i princip gäller än idag. 3, 4
Därutöver kompliceras bilden av att Sverige år 1988 fick en ny djurskyddslag som innehöll regler för uppfödning med fokus på välfärd vilket ibland förväxlas med förbudet mot att använda tillväxt befrämjare. Den nya lagen innebar bland annat att
Kungl. Skogs- och Lantbruksakademiens TIDSKRIFT
46
FÖREGÅNGSLANDET SVERIGE
nr 5 2022
Lena Eliasson-Selling
suggor skulle hållas lösgående och större golvytor krävdes för att hålla grisar. Förändringarna infördes successivt under 1989.
Sammanfattningsvis kan sägas att arbetet mot antibiotikaresistens inte varit en pålaga för näring en utan initiativet har ofta kommit från djurägarna själva i samarbete med deras veterinärer. Även för budet 1986 mot tillväxthormoner var väl förankrat och understött av djurägarna (LRF). Men det fanns naturligtvis även djurägare som inte var glada över dessa initiativ.
Sjukdomsförebyggande åtgärder
Från frivillig till reglerad hälsokontroll
Svenska djurägare har i generationer varit medvetna om effekten av förebyggande grishälsovård och tog själva initiativ till hälsokontroll och förebyggande hälsovård för grisar med anställda veterinärer på hushållningssällskapen på 1940-talet. Staten antog
detta arbetssätt 1969 och en offentlig hälsokon troll instiftades. Staten gav näringens veterinärer i uppdrag att sköta den offentliga hälsokontrollen. Veterinärerna anställdes då av slakteriföreningarna.
I samband med att slakteriorganisationen omor ganiserades 1999 och föreningarna försvann bilda des Svenska Djurhälsovården AB, som 2015 bytte namn till Gård & Djurhälsan AB och numera är ett dotterbolag till Svenska Köttföretagarna. För några år sedan ansökte Lundens Djurhälsa och Distriktsveterinärerna om att få driva offentlig djurhälsokontroll. Idag finns således tre aktörer som arbetar med hälsokontroll för djurslaget gris.
Vi har också en unik historisk öppenhet i det svenska samhället, som även gäller den agrara sek torn där vi registrerar sjukdomar, antibiotikaför brukning och numera även produktionsplatsnum mer samt alla förflyttningar av lantbrukets djur. Detta är en av förutsättningarna för en fungerande förebyggande hälsokontroll.
Miraklet som skapat ett monster – antibiotikaresistens/AMR med fokus på djur

47 FÖREGÅNGSLANDET SVERIGE
Djurskyddslagen från 1988 innebar bland annat att suggor skulle hållas lösgående och större golvytor krävdes för att hålla grisar.
Foto: Kameron Kincade.
Sverige har också en lång historia av att aktivt bekämpa farsoter hos lantbrukets djur vilket bidragit till vårt goda utgångsläge för att bedriva förebyggande hälsovård. 2 Efter EU-inträdet 1995 tog näringen initiativ till Svenska Djurbönders Smittskyddskontroll (SDS).5 SDS uppdrag är att utöva utökad kontroll vid import av levande djur, embryon och sperma, vilket bidrar till att bibehålla vårt goda hälsoläge. Ett gott hälsoläge är den viktigaste förut sättningen för en låg antibiotikaförbrukning.
Yttre och inre smittskydd, införande av omgångsproduktion – ett viktigt led i arbetet mot AMR
Redan under 1950-talet påbörjades tanken på ”allt in/allt ut”, det vill säga omgångsuppfödning i slakt grisledet. Historiskt hade grisproduktionen varit uppbyggd av många små smågrisproducenter som sålt sina grisar till gårdar som bedrev specialiserad slaktgrisuppfödning, vilket då innebar en bland ning av smittor från flera gårdar. Ett första steg att bryta smittkedjorna skapades genom att stallarna tömdes helt vid slakt och rengjordes. Förutom att hälsoläget blev bättre skapades förutsättningar för en effektiv produktion då lika gamla (och tunga) smågrisar kunde sättas in för uppfödning och se dermera slaktas samtidigt. Omgångsuppfödningen var uppfunnen.
Strukturomvandlingen inom grisnäringen har medfört att besättningarna nu är färre men större. Det är således färre leverantörer till varje omgång av smågrisar och risken för infektioner minskar. Allt oftare föds smågrisarna upp till slakt i integrerade system där de antingen föds upp på hemmagården, eller förmedlas till en och samma slaktgrisprodu cent i ett så kallat externintegrerat uppfödningssys tem. Ett frivilligt smittskyddsprogram, Smittsäkrad Besättning Gris, startades 2016.6 Målet var att höja smittskyddet i landets grisbesättningar så att ut brott av smittsamma sjukdomar kunde förhindras. Programmet godkändes av Jordbruksverket och drivs i samarbete mellan Sveriges Grisföretagare, Gård & Djurhälsan, Lundens Djurhälsa och Distriktsveterinärerna.
Förbudet mot lågdosantibiotika ledde med tiden till att den ålderssegregerade uppfödningen kom mit att omfatta alla led i uppfödningen, det vill säga redan från grisning. Detta innebar att grupper av dräktiga suggor flyttades till tomma och rengjorda
grisningsstallar där de grisade inom några dagar. Målet var att avvänja grupper av lika gamla, robusta och friska smågrisar som klarade avvänjningen och tillväxtperioden bra, vilket har medfört en positiv inverkan på hälsoläget inom hela uppfödningsked jan.
En förutsättning för omgångsuppfödningen var att suggorna i en omgång grisade och efter 4–5 veckors digivning avvandes kultingarna samtidigt, suggorna visade då brunst efter några dagar och betäcktes samtidigt. Metoder för att arbeta med brunstpassning och insemination som bygger på suggornas naturliga beteende utvecklades.7 Detta visade sig fungera väl i de lösdriftssystem för suggor som introducerades i stor skala under 1990-talet och som idag kännetecknar den svenska grisproduktio nen men som ännu inte är utbrett i andra länder.8 Det är också viktigt att komma ihåg att denna ut veckling inte varit möjlig utan en fungerande inse minationsverksamhet.
Eftersom omgångsuppfödningen krävde att många suggor betäcktes samtidigt var det i prak tiken inte längre möjligt med naturlig betäckning så användningen av artificiell insemination utveck lades. Idag sker mer än 95 procent av suggbetäck ningarna med hjälp av insemination. Det finns två galtstationer som producerar sperma till Sveriges grisbesättningar.9 Dessa är hälsokontrollerade och ingår i övervakningsprogram för smittsamma sjuk domar.
I den svenska modellen med lösgående suggor i grisningsboxarna underlättas suggornas normala beteende, såsom bobyggnad, grisning och igångsät tande av digivning, vilket påverkade mjölkproduk tionen positivt och därmed tillväxten av den diande smågrisen.10 Vi avvänjer på så vis tunga, robusta och friska smågrisar som har förutsättningar att klara avvänjningen utan zink och antibiotika.
I Sverige diar smågrisarna en längre tid jämfört med andra länder, i genomsnitt 32,7 dagar jämfört med 26,4 dagar (figur 1).11 Avvänjningen innebär trots detta alltid en stress för smågrisen då tarmflo ran ska anpassa sig till ett foder baserat på växtpro tein. Följden kan bli att grisen drabbas av så kallad avvänjningsdiarré, orsakad av elakartade kolibakte rier, en diarré som måste behandlas med antibiotika. Ett hjälpmedel som har använts och används för att förebygga avvänjningsdiarré är att blanda in zink i smågrisfodret. Det är välkänt att zink kan påverka tarmfloran och lindra utvecklingen av avvänjnings
Kungl. Skogs- och Lantbruksakademiens TIDSKRIFT nr
48
FÖREGÅNGSLANDET SVERIGE
5 2022
diarré. I juni 2022 förbjöds zinkinblandning i gris foder i hela EU på grund av negativa effekter på miljön och sambandet med utveckling av resistens hos bakterier. Inför denna förändring hade Gård & Djurhälsan AB reviderat tidigare rådgivningsmate rial för att förebygga avvänjningsdiarré i samarbete med näringen.12, 13 Med detta arbetsmaterial som grund genomförs intensifierade rådgivningsinsatser.

Smågrisarna föds därefter upp från avvänjning till insättning i separata tillväxtstallar och flyttas sedan till slaktgrisstall, vid cirka 30 kilos kropps vikt. Systemet skapar förutsättningar inte bara för en omgångsproduktion utan även för en så kallad ”ålderssegregation”. Det här uppfödningssättet är grunden för den svenska uppfödningen av friska små- och slaktgrisar.
Miraklet som skapat ett monster – antibiotikaresistens/AMR med fokus på djur

49 FÖREGÅNGSLANDET SVERIGE
Figur 1. Interpig 2021, digivningstid 2016–2020.11 2016–2020 2020 35 30 25 20 15 10 5 0 Dagar Österrike Belgien Brasilien Tjeckien Danmark Finland Frankrike Tyskland Storbritannien Ungern Irland Italien Nederländerna Spanien Sverige USA 27,0 23,3 28,0 23,7 31,0 30,8 24,1 24,5 26,6 28,0 30,0 27,0 27,3 24,2 32,3 22,0
I den svenska modellen med lösgående suggor i grisningsboxarna underlättas suggornas normala beteende. Det påverkar mjölkproduktio nen positivt och därmed smågrisarnas tillväxt. Foto: Pixabay. DIGIVNINGSTID
Diarré
ANTIBIOTIKABEHANDLADE SJUKDOMSFALL PER 1000 Antal fall
SLAKTADE GRISAR 100% 90% 80% 70% 60% 50% 40% 30% 20% 10% 0%
Diarré
Ledinflammation Symptom på infektionssjukdom Svindysenteri Pellesyndromet Annat
Klok användning av antibiotika
I Sverige är förekomst av sjukdomar bland grisar of tast relaterad till omgivningsfaktorer (management). De vanligaste är infektionssjukdomar, oftast orsa kade av bakterier.
Sverige är fritt från flertalet globalt viktiga virus sjukdomar. Övervakningsprogram för PRRS (por cine respiratory reproductive syndrom), AD (Aujeszky’s disease), salmonella och MRSA (methicillin resistent staphylococcus aureus) är finansierade av staten och obligatoriska i utvalda besättningar. Provtagning sker på gård och vid slakt.

De flesta grisbesättningar idag är anslutna till villkorad behandling (VILA).14 De har rutinmässiga veterinärbesök och skriftliga rutiner för hur antibio tika ska användas på besättningsnivå. Djurskötarna som behandlar sjuka grisar måste ha genomgått en utbildning. Besättningsveterinärer rapporterar läkemedelsförbrukningen till Jordbruksverket. De kli niska iakttagelserna av sjukdomar kompletteras med regelbunden diagnostik med hjälp av laboratorieana lyser och/eller obduktioner för att identifiera såväl bakteriella sjukdomar som resistensläget för dessa.
Vaccinationer mot infektionssjukdomar var och är ett viktigt arbetsredskap i samtliga led i grisupp födningen
Kungl. Skogs- och Lantbruksakademiens
50
nr 5 2022 FÖREGÅNGSLANDET SVERIGE
TIDSKRIFT
Resultat från en undersökning av antibiotika användning under 2017 i 147 svenska slaktgrisbe 600 500 400 300 200 100 0
Fördelning av behandling på diagnos, slaktgrisar
Bes
1 Bes 2 Bes 3 Bes 4 Bes 5
Figur 2. Antibiotikabehandlade sjukdomsfall per 1000 slaktade grisar 2017.15 sättningar (30 procent av årsslakten) presenterades 2019.15 Slutsatsen var att de flesta slaktgrisuppfödare behandlade inga eller väldigt få grisar i slaktgrisledet (figur 2). Om behandling behövdes skedde det med optimal användning av antibiotika till sjuka djur. Arbetssättet inför behandling inkluderade också obduktion, provtagning och resistensbestämning. I huvudsak utfördes individuell behandling av en staka djur, men vid utbrott kunde foder-/vattenme dicinering användas.
Hur är det idag? Reflektion från djurägarna Hur upplevde grisproducenterna förbudet mot tillväxtbefrämjande antibiotika 1986 och målsätt ningen att även i övrigt reducera användningen av antibiotika i djurhållningen?
Det svenska beskrivna arbetssättet ovan är väl förankrat i grisnäringen och svensk grisuppfödning hävdar sig väl i den internationella konkurrensen. Svenska slaktgrisar har enligt den internationella rapporten Interpig 2021 den bästa tillväxten från födsel till slakt, 705 gram per dag jämfört med 547 gram per dag som är lägst (figur 3).11 Den längre digivningen medförde att robusta och friska små grisar avvandes, som klarade uppfödningstiden bra. Dödligheten från avvänjning till insättning i slakt lik-
som dödligheten under slaktgrisperioden var lägre i Sverige, i jämförelse med 14 andra länder; 2,05 pro cent jämfört med 3,2 procent för tillväxtgrisar och 1,7 procent jämfört med 2,9 procent för slaktgrisar. Däremot var smågrisdödligheten 4 procent högre.
Det är 36 år sedan vi förbjöd användningen av tillväxtstimulerande lågdosantibiotika i våra grisfo der. Det har gått tre generationer på en del gårdar. Den senaste unga generationen är inte ens medveten
Referenser
1. https://www.sva.se/media/0hihej1c/swedres-svarm-2019.pdf
om att vi har använt antibiotika som tillväxtstimule rande i foder åt våra grisar.
Dagens generation grisföretagare svarar när jag ställer frågan hur det gick att reducera antibiotika användningen 1986 att det är en icke-fråga. Idag är den svenska modellen att föda upp grisar med ål dersektionerad omgångsuppfödning ett väletablerat effektivt, rationellt och produktivt arbetssätt.
2. Wierup, M., Wahlström, H., Bengtsson, B. Successful Prevention of Antimicrobial Resistance in Animals – A Retrospective Country Case Study of Sweden. Antibiotics 2021, 10, 129. https://doi.org/10.3390/antibiotics10020129
3. Swedish Veterinary Association. Riktlinjer för antibiotikainblandning i foder till svin. Sven. Vet. Tidn. 1990, 42, 407–413.
4. Swedish Veterinary Association. Sveriges Veterinärförbunds antibiotikapolicy. Sven. Vet. Tidn. 1999, 51, 38–40.

5. http://www.sds-web.se
6. http://www.xn--smittskra-02a.se/gris/smittsakrad-besattning-gris/
7. Eliasson-Selling, L., Hofmo, P.-O., Narum, M. 2000. The art of oestrous-control in group-housed sows – a video presentation, Proc. 16th IPVS, Melbourne, Australia, 395.
8. Einarsson, S., Sjunnesson Hultén, F., Eliasson-Selling, L., Dalin, A.-M., Lundeheim, N., Magnusson, U., 2014. A 25 years’ expe rience of legislation regarding loose-housed sows-reproduction in animal friendly systems. ACTA VET SCAND, 56:37.
9. https://www.kottforetagen.se/grisgenetik.html
10. Yun, J., Swan, K.-M., Oliviero, C., Peltoniemi, O., Valros, A. Effects of prepartum housing environment on abnormal behaviour, the farrowing process, and interactions with circulating oxytocin in sows. Appl Anim Behav Sci. 2015; 162:20–25.
11. https://www.gardochdjurhalsan.se/wp-content/uploads/2021/12/Internationella-rapporten-2021-v2.pdf
12. https://www.gardochdjurhalsan.se/wp-content/uploads/2021/06/nya-avvanjningsboken-2021_digital.pdf 13. https://utanzink.se/ 14. https://www.gardochdjurhalsan.se/villkorad-lakemedelsanvandning-en-forman-med-forbehall-2/ 15. Clemensson Lindell, I., Lindahl, E., Lundeheim, N., Eliasson-Selling, L. 2019. Antibiotic treatments in Swedish pig herds, as number of treated cases per 1000 animals at risk. Proc.11th ESPHM 2019, HHM-PP-47, Utrecht, NL.
Miraklet som skapat ett monster – antibiotikaresistens/AMR med fokus på djur
51 FÖREGÅNGSLANDET SVERIGE
750 700 650 600 550 500 Gram per dag
685 658 679 677 676 692 666 680 669 639 633 653 643 627 547 641 627 546 625 595 593 654 630 584 565 692 681 680 TILLVÄXT FRÅN FÖDSEL
708 705
Figur 3. Interpig 2021, tillväxt, gram per dag, från födsel till slakt.11
Brasilien Kanada Tjeckien Danmark Finland Frankrike Tyskland Storbritannien Ungern Irland Italien Nederländerna Spanien Sverige USA
TILL SLAKT
2016–2020 2020
Samverkan och statligt ansvar
–framgångsfaktorer bakom Sveriges låga bruk av antibiotika i animalieproduktionen
Martin Wierup
Lantbrukets djur i Sverige har den lägsta förbruk ningen av antibiotika inom EU:s medlemsländer. Sverige tillhör dessutom de länder som har lägst förekomst av antibiotikaresistens (AMR). Denna situation är unik i ljuset av att de växande problemen med AMR nu utgör ett av de allvarligaste hoten mot den globala folk- och djurhälsan. WHO, FAO och WOAH (tidigare OIE) gör därför stora satsningar för att vända utvecklingen och har bland annat sökt exempel på framgångsrika insatser mot AMR att tjäna som förebild. Som ett svar på detta upprop har med början från förra sekelskiftet Sveriges insatser analyserats, för att identifiera de faktorer som lett till vår fördelaktiga situation.
Analysen, som granskats av ett 20-tal svenska nyckelpersoner som på olika sätt varit engagerade i dessa frågor, har fokuserat på tre områden: 1) kon troll av infektionssjukdomar eftersom det minskar behovet av antibiotika, 2) åtgärder mot AMR, sär skilt korrekt användning av antibiotika, samt 3) stra tegin för genomförandet av olika åtgärder. Adressen till källmaterial och den fullständiga studien finns i slutet av denna artikel medan de viktigaste fram gångsfaktorerna kan ges följande beskrivning.
Veterinär infrastruktur för bekämpande av smittsamma (epizootiska) djursjukdomar Bidragande till dagens fördelaktiga situation är att staten redan på tidigt 1900-tal tog ledningen för bekämpandet av allvarliga epizootisjukdomar (ta bell 1). Betydande insatser gjordes för att inte bara kontrollera utan också utrota dessa så att de inte fick fotfäste i landet och åter kunde blossa upp. Tidigt genomfördes också omfattande nationella program för utrotning av andra förlustbringande infektions sjukdomar och trots en omfattande spridning kunde både bovin tuberkulos och bovin brucellos utrotas
årtionden före andra europeiska länder (tabell 1). Det kan uppskattas att ca 60–70 procent av de svenska mjölkkorna var infekterade med bovin tu berkulos och som mest genomfördes på 1940-talet årligen 1,1 miljoner tuberkulinundersökningar för att identifiera och slakta ut de smittade djuren. Dessa insatser krävde uppbyggnad av en veterinär infra struktur med diagnostiska laboratorier, som senare blev värdefulla verktyg för att förebygga och kon trollera också endemiska sjukdomar. Som en avgö rande insats framstår även den aktiva kontrollen av salmonella som inleddes för mer än 60 år sedan och har resulterat i en nästan salmonellafri djur- och foderproduktion, i ett internationellt perspektiv en unik och avundsvärd situation.
Unik strategi för förebyggande av vanligt förekommande (endemiska) djursjukdomar År 1945 började branschledda rådgivande organisationer tillhandahålla hälsorådgivning (ofta kallad hälsokontroll) för att hjälpa djurproducenter att förebygga och kontrollera förlustbringande endemiska sjukdomar. Främst gällde det olika luftvägs- och mag tarminfektioner, som följde med den specialiserade djurhållningen. Denna service har därefter utvecklats och används i dag av nästan 100 procent av de kommersiella primärproducenterna. Som ett led i denna utveckling introducerade staten 1969 den organise rade hälsokontrollen. Den möjliggjorde för bransch organisationer att med statligt finansieringsstöd etablera program för organiserad hälsokontroll för specifika endemiska sjukdomar av nationell betydelse. Programmen följer statliga riktlinjer och övervakas av ansvarig myndighet. Detta samarbete mellan in dustrin och staten har möjliggjort kontroll och ut rotning av en rad av viktiga sjukdomar (tabell 2).
Kungl. Skogs- och Lantbruksakademiens TIDSKRIFT
52
5 2022 FÖREGÅNGSLANDET SVERIGE
nr
År Sjukdom Djurslag
Kommentarer
1924–1927 Mul- och klövsjuka Nötkreatur 11 002 besättningar infekterade.
1934–1958 Bovin tuberkulos Nötkreatur
1937: makroskopiska fynd hos 30 % av slaktade nötkreatur (indikerar att 60–70 % av alla nötkreatur var infekterade).
1938–1940 Mul- och klövsjuka Nötkreatur 7 293 besättningar infekterade.
1940 Klassisk svinpest Grisar 230 besättningar infekterade.
1943–1944 Klassisk svinpest Grisar 445 besättningar.
1944–1962 Bovin brucellos Nötkreatur 1944: 16 000 (6 %) besättningar infekterade.
1950–1956 Paratuberkulos Nötkreatur Köttdjur, 830 djur seropositiva.
1951–1952 Mul- och klövsjuka Nötkreatur 562 besättningar infekterade, 1 miljon djur vaccinerade.
1953 Salmonellaepidemi I huvudsak nötkreatur 9 000 humana fall, 90 dödsfall.
1956–1957 Porcin brucellos Grisar 76 besättningar infekterade.
1956–1957 Antrax Nötkreatur/grisar 19 nötkreaturs- och 68 grisbesättningar infekte rade.
1960 Mul- och klövsjuka Nötkreatur 6 besättningar infekterade.
1991–1997 Bovin tuberkulos Hägnad hjort 13 besättningar infekterade.
1993 Paratuberkulos Nötkreatur 53 köttdjursbesättningar infekterade.
1995–1996 Newcastlesjuka Fjäderfä 650 flockar testade, 1,75 miljoner fåglar/ägg destruerade.
2007 Porcine reproductive and respi ratory syndrome (PRRS) Grisar 7 besättningar infekterade, modifierad ”stamping out”.
2008–2009 Blåtunga Nötkreatur 30 utbrott i olika regioner, 1 miljon djur vaccinerade.
2010–2020 Högpatogen aviär influensa och Newcastlesjuka Fjäderfä 2 respektive 5 utbrott.
2010–2020 Antrax Nötkreatur 12 utbrott.
Tabell 1. Större utbrott av viktiga epizootiska sjukdomar i Sverige mellan 1900 och 2020. Modifierad från Wierup et al. (2021).
År Sjukdom
Djurslag Kommentarer
1990–2001 Enzootisk bovin leukos Nötkreatur
Initialt, 25 % av mjölkkobesättningarna infekterade. Utrotad.
1991–1996 Aujeszky’s sjukdom Grisar Initialt, 5 % av suggbesättningarna infekterade. Utrotad.
1993–2013 Bovin virusdiarré Nötkreatur Initialt, 40 % besättningsprevalens. Nationell frihet dekla rerad 2014.
1993– Maedi-Visna Får Initialt, 8,2 % besättningsprevalens. Övervakas för att verifiera fria besättningar för livdjurshandel.
1993– Campylobacter spp. Slaktkyckling Övervakning med mål att reducera förekomst.
1994–1998 Infektiös bovin rhinotrakeit Nötkreatur Initialt, 0,2 % av mjölkbesättningarna sero-positiva. Utrotad.
1998–2017 Paratuberkulos Nötkreatur Upprepade introduktioner i köttdjursbesättningar via im porter, senaste fallet 2005. Mjölkkobesättningar har aldrig infekterats. Övervakas för att dokumentera mycket låg förekomst eller för att om möjligt deklarera nationell frihet.
1998– Porcine reproductive and respi ratory syndrome (PRRS) Grisar
Ett utbrott 2007. Nationell frihet deklarerad 2008.
Tabell 2. Exempel på sjukdomar som enligt EU:s bedömning har utrotats i Sverige eller omfattas av kontroll genom organiserad hälsokontroll i Sverige. Modifierad från Wierup et al. (2021).
Miraklet som skapat ett monster – antibiotikaresistens/AMR med fokus på djur
53 FÖREGÅNGSLANDET SVERIGE
Konstruktionen av den organiserade hälsokon trollen har sitt ursprung i en genial formulering i Veterinärväsendeutredningen (1968), där den tyvärr okände författaren skriver att man genom en orga niserad hälsokontroll kan få branschens hälsoverk samhet att arbeta så att det även gagnar landet. Detta tidiga vägval för kontroll av endemiska sjukdomar är troligen unikt för Sverige och framstår som en avgörande framgångsfaktor till vår låga användning av antibiotika. Trots att dessa sjukdomar utgör den största måltavlan för användning av antibiotika, är de i ett internationellt perspektiv sällan föremål för statligt initierad kontroll (figur 1).

Tidigt fokus på AMR och minskat behov av antibiotika
Redan på 1950-talet uppmärksammade svenska veterinärer, forskare och djuruppfödare risken för AMR och på 1960-talet diskuterades behovet av ansvarsfull användning av antibiotika. Under föl jande decennier uppmärksammades antibiotikaanvändningen för djur också alltmer i den allmänna samhällsdebatten. Som en följd föreslog LRF att användning av antibiotika i tillväxtbefrämjande syfte skulle förbjudas vilket Sverige 1986 gjorde som
första land. Förbudet ledde till ett extra fokus på sjukdomsförebyggande åtgärder – utan antibiotika.
Data över AMR och användning av antibiotika
Tillgången till data över förekomsten av AMR se dan slutet av 1950-talet och sedan 1980, också som första land, över användningen av antibiotika, gjorde det möjligt att identifiera och fokusera på problem områden, formulera riktlinjer och lagstiftning för användningen av antibiotika samt att utvärdera vid tagna åtgärder. En allmän medvetenhet om AMR omvandlades därmed till en konkret förståelse av problemet som möjliggjorde åtgärder för att mot verka uppkomsten av AMR.
Riktade åtgärder mot specifik resistens
Riktade åtgärder har också vidtagits för att motver ka spridningen av bakterier med allvarlig resistens. En policy för behandling av juverinflammation hos mjölkkor minskade förekomsten av penicillinresistent Staphylococcus aureus från 10 procent till 1 pro cent genom att rekommendera att kor infekterade med den resistenta bakterien bör slaktas snarare än
Kungl. Skogs- och Lantbruksakademiens TIDSKRIFT
54
FÖREGÅNGSLANDET SVERIGE
nr 5 2022
Uppskattad global kostnad hos människor och djur av djurens infektionssjukdomar som indikerar kostnadens relativa storlek (produktions- och arbetskraftsförluster och kostnader för bekämpning och kontroll och medicinsk vård). Källa:
Ebi, i International Assessment of Agricultural Knowledge, Science and Technology for Development
2009. GLOBAL LAGSTIFTNING FÖR KONTROLL AV INFEKTIONSSJUKDOMAR* GLOBAL BELASTNING AV INFEKTIONSSJUKDOMAR *) Förutom nationell och internationell lagstiftning relaterad till livsmedelssäkerhet (CODEX). WOAH Betydande epizootiska sjukdomar Betydande epizootiska sjukdomar WOAH Betydande zoonotiska sjukdomar Andra betydande zoonotiska sjukdomar Ingen global lagstiftning för återstående sjukdomar Endemiska sjukdomar
Figur 1.
M. Wierup and K.
(IAASTD),
behandlas. Andra exempel är de riktade åtgärder som vidtogs för att begränsa förekomst av tiamu linresistent Brachyspira hyodysenteriae (som orsakar svindysenteri), meticillinresistenta stafylokocker (MRSA/MRSP) och bakterier med resistens mot tredje generationens cefalosporiner (ESBL/AmpC), som båda ger svårbehandlade infektioner på människor.
Statligt ledarskap för samarbete och problemlösning
Genom sina reglerande och finansiella verktyg, piska och morot, särskilt genom organiserad hälso kontroll, har den ansvariga veterinärmyndigheten framgångsrikt möjliggjort och underlättat aktivt förebyggande och kontroll av infektionssjukdomar och AMR. Genom etablering av samarbete mellan olika intressenter har en ömsesidig förståelse för be hovet och fördelarna med att genomföra åtgärder ofta skapats.
Kontroll av import och av inhemsk handel med djur, gener och foder har varit särskilt betydelsefull och motverkat spridningen till och inom landet av flera viktiga sjukdomar, däribland två med pande misk spridning, den äggburna Salmonella Enteritidis och grissjukdomen PRRS (porcine reproductive and respiratory syndrome). Pådrivande har även varit att användningen av antibiotika blivit en viktig fråga på den politiska dagordningen och för konsumenter.
Veterinär närvaro på gårdarna
Producenter som använder organiserade hälsovårds tjänster eller deltar i organiserade hälsokontrollpro
gram får regelbundna besök av veterinärer. Detta leder till en veterinär insyn i besättningarna men ger också producenterna tillgång till veterinär expertis och sjukdomsspecifik rådgivning och underlättar implementering av antagna riktlinjer för exempelvis biosäkerhet och användning av antibiotika.
Ekonomin – en avgörande faktor Kontrollen av smittsamma sjukdomar och AMR kostar pengar men är i längden lönsam. Oförmågan att nationellt fördela kostnaden mellan olika aktö rer med vitt skilda intressen är därför ofta orsaken till att nödvändiga åtgärder inte blir genomförda. Kontroller och utrotande av endemiska sjukdomar före Sveriges EU-inträde 1995 betalades till stor det av staten. Därför riskerade svensk produktion inte som i dag, att temporärt på grund av ökade kostna der, slås ut av utländsk konkurrens. Före EU-inträdet kunde Sverige dessutom begränsa konkurrerande import. Som den avgörande framgångsfaktorn för att nå dagens fördelaktiga situation framstår likväl att Sverige tidigt insett behovet av, och haft förmå gan till, ett nationellt agerande mot de smittsamma sjukdomarna och AMR. Sverige har därför, ofta långt före andra länder, konsekvent och målinriktat framgångsrikt genomfört en rad resurskrävande och sjukdomskontrollerande åtgärder. Inför framtiden är det nödvändigt att vi behåller och utvecklar denna förmåga särskilt inom ramen för ett EU-samarbete. Vi kan inte vila på lagrarna med hänvisning till att vi på områden som kontrollen av salmonella och förbu det mot foderantibiotika påverkat EU och att unio nens djurhälsoarbete nu styrs av den svenskinspire rade målsättningen ”Prevention is better than cure”.
I Sverige är antibiotikaförbrukningen hos djur i lantbruket lägst i EU – och Sverige tillhör de länder som har lägst förekomst av antibiotikaresistens. Foto:
Miraklet som skapat ett monster – antibiotikaresistens/AMR med fokus på djur

55 FÖREGÅNGSLANDET SVERIGE
Källa
Wierup, M., Wahlström, H., Bengtsson, B. Successful Prevention of Antimicrobial Resistance in Animals – A Retrospective Country Case Study of Sweden. Antibiotics 2021, 10, 129. https://www.mdpi.com/2079-6382/10/2/129
Ylva Nordin.
Avslutande reflexioner
Arbetet med detta nummer av KSLAT, fokuserat på antibiotikaresistens och AMR, har varit en ögon öppnare också för oss i redaktionsgruppen. Strålkastarljuset har riktats mot aspekter, som tidigare inte var tillräckligt synliga, som att antibiotika och antimikrobiella medel används även inom växtodlingen, som att produktionen av råvarusubstanser till antibiotika och andra antimikrobiella medel sker under totalt oacceptabla förhållanden och utan tillräckligt starka reaktioner från omvärlden.
Det är också alldeles uppenbart att även om arbetet mot ökad resistens förs på många olika håll i världen, så är det som görs i dag alldeles otillräckligt. Arbetet måste intensifieras och fler aktörer måste involveras. Avslutningsvis vill vi här i några korta reflexioner peka på aspekter som vi finner särskilt viktiga att lyfta fram i det fortsatta arbetet.
För att komma till rätta med antibiotikaresistensen långsiktigt räcker inte att enbart arbeta på nationell eller regional nivå. Frågan är global och problematiken liknar på flera sätt två andra ödesfrågor vi brottas med, klimatet och förlusten av biologisk mångfald. Gemensamt för alla tre är att naturliga system är sam mantvinnade med vårt sätt att leva, med vår kultur, vår ekonomi och hur vi organiserar våra samhällen –världen över. Det finns helt enkelt inga ”end-of-pipe-lösningar”. Varje människas insats är nödvändig – men otillräcklig! Vad som krävs är samarbete, på global, regional och nationell nivå. Det viktiga One Health arbetet (djurs och människors hälsa i ett sammanhang) måste intensifieras och det med ett ökat fokus på djursidan (och även på växtodlingen).
Klarar vi inte att globalt reducera och införa en ansvarsfull användning av antibiotika inom såväl jordbruk som sjukvård så ökar risken att världen inom en snar framtid står utan möjligheter att behandla livshotande bakteriella sjukdomstillstånd.
En starkt bidragande orsak till resistensutvecklingen i världen är att tillverkningsindustrin i Kina och Indien inte har tillräckligt strikta miljölagar och inte kontrollerar efterlevnaden av de regelverk som finns, utan släpper ut aktiva antibiotikasubstanser i lokala, ofta bakteriellt förorenade, vattendrag. Dessa bakterier tillägnar sig resistens. Resistensproblematiken kommer inte att kunna mötas om inte kraven på och kontrol len av tillverkningsindustrin drastiskt skärps.
Sverige visade först av alla länder att det på nationell nivå går att minska antibiotikaanvändningen inom djurhållningen. Sverige var också framgångsrikt som EU-medlem i att inom ramen för samarbetet där ar beta för minskad antibiotikaanvändning. Även om den svenska erfarenheten inte kan överföras till en global nivå så finns kunskap att hämta, bland annat kring effekten av en minskad antibiotikaanvändning liksom hur arbetet praktiskt kan bedrivas. Det är angeläget att de svenska erfarenheter och kunskaper som byggts upp förs ut i det internationella arbetet.
Men det är i detta sammanhang också nödvändigt med en viss ödmjukhet och att vi inser att villkoren för arbetet är mycket olika i skilda delar av världen. Man kan ibland i internationella sammanhang få höra, lite retsamt (men allvarligt menat), att Sverige kännetecknas av en viss ”besserwisser-attityd” – ”In Sweden we have a system...”. Det är inte en exakt kopia av Sveriges process och modell, som ska tryckas ut i andra länder. De kunskaper och erfarenheter som vi ska dela med oss av måste alltid anpassas till sina nya sammanhang.
Vi måste också hålla i våra framsteg, inte tappa bort dem i tuffare ekonomiska tider. Att vi varit och är ledande nu är ingen garanti för framtiden. Det ligger ett dagligt hårt arbete bakom framgången. Enskilda aktörer måste i detta fortsatt få samhällets stöd. Staten måste fortsätta att ta ett stort ansvar ekonomiskt och på andra sätt för att det ska vara möjligt. Vi har i redaktionsgruppen ställt oss frågan om den svenska framgången hade varit lika självklar idag inom ramen för den jordbrukspolitik som nu råder.
Kungl. Skogs- och Lantbruksakademiens TIDSKRIFT nr 5 2022
56
Arbetet inom EU visar att det går att nå resultat kring gemensamma lagar och regelverk. Framöver blir det viktigt att agera så att EU:s nya lagstiftning får genomslag. Miljö- och hälsoperspektivet liksom kontrol lens efterlevnad måste uppgraderas i förhållande till frihandelsintresset. Det är också viktigt, som flera av artiklarna i detta nummer visar, att enskilda aktörer kan fördjupa arbetet och gå längre än lagstiftningen kräver där skarpa regler inte finns på plats. Aktörer utanför politik och myndigheter måste ta sitt ansvar, KSLA:s och Axfoundations gemensamma plattform och de kriterier som Axfoundation tagit fram visar på möjligheter. Det arbetet måste fortsätta.
Arbetet mot antibiotikaresistens, i Sverige och internationellt, domineras av verksamhet på olika policy nivåer. Plattformen vill fokusera på marknadens aktörer och andra krafter i samhället utanför politik- och myndighetsstrukturer. Plattformen ger stöd till dem som arbetar med frågorna i sin vardag. Inom ramen för plattformsarbetet vill vi också lyfta fram och belysa områden som är viktiga men som hittills inte upp märksammats tillräckligt.
Sist – men inte minst – vill vi understryka betydelsen av forskning och utbildning. SLU och andra lärosäten är här av stor betydelse, genom sina utbildningar och genom sin forskning och sitt forskningssamarbete med kollegor och samverkan med samhället världen över.
Redaktionsgruppen
Marianne Elvander
Per Eriksson
Maria Lundesjö
Jimmy Lyhagen Annika Åhnberg
Miraklet som skapat ett monster – antibiotikaresistens/AMR med fokus på djur
57
Ordlista och akronymer
AMR Antimikrobiell resistens hos bakterier, virus, svampar eller parasiter (används dock ofta för antibiotikaresistens hos bakterier).
AMU Antimicrobial Use, bruk av antimikrobiella substanser.
Antibiotika Läkemedel som används för att behandla infektioner orsakade av bakterier.
Antibiotikaresistens Utvecklad motståndskraft mot antibiotika.
Antimikrobiella medel Ämnen som dödar eller förhindrar förökning av mikroorganismer, exempelvis bak terier eller svamp.
API Active Pharmaceutical Ingredient, aktiv farmakologisk substans.
Biosimilar Ett biologiskt läkemedel som är mycket likt ett annat biologiskt läkemedel som redan är godkänt för försäljning inom EU (referensläkemedel).
CGIAR Consultative Group for International Agricultural Research.
DNA Deoxiribonukleinsyra, det kemiska ämne som bär den genetiska informationen, det vill säga varje individs arvsmassa och arvsanlag.
EEA/EES European Economy Area/Europeiska ekonomiska samarbetsområdet.
Endemiska sjukdomar Vanligt förekommande sjukdomar i ett land eller region.
EPA Environmental Protection Agency, federal miljöskyddsmyndighet i USA.
Epizooti Allvarlig smittsam djursjukdom.
ESBL Extended Spectrum Beta-Lactamase. Tarmbakterier som bildar ESBL har ämnen som bryter ned de flesta antibiotika ur penicillingruppen och gör att dessa inte kan användas.
ESVAC The European Surveillance of Veterinary Antimicrobial Consumption.
FAO The Food and Agriculture Organization of the United Nations.
GARP Global Antibiotic Resistance Partnership.
Generika Ett läkemedel som innehåller samma aktiva farmaceutiska substanser (API) som orginalprodukten, vilken förlorat sitt patentskydd och dokumentationsskydd.
GMP Good Manufacturing Practices, krav på god tillverkningssed.
LRF Lantbrukarnas Riksförbund.
Metafylax Behandling av grupp av djur.
MRSA Methicillin Resistent Staphylococcus Aureus, meticillinresistenta stafylokocker.
Mutation Förändringar i arvsmassan, kan ske spontant eller genom yttre påverkan.
One Health-perspektiv Ett integrerat, förenande tillvägagångssätt för att balansera och optimera hälsan hos människor, djur och miljö.
Patogener Sjukdomsframkallande smittämnen.
Kungl. Skogs- och Lantbruksakademiens TIDSKRIFT nr 5 2022
58
Profylax Förebyggande behandling.
PRRS Porcine Reproductive and Respiratory Syndrome, porcint reproduktivt och respira toriskt syndrom.
PSCI Pharmaceutical Supply Chain Initiative.
SDS Svenska Djurbönders Smittskyddskontroll.
Sjömat Fisk och skaldjur.
SLU Sveriges lantbruksuniversitet.
SLV Livsmedelsverket.
SVA Statens veterinärmedicinska anstalt.
SvDH Svensk Dagligvaruhandel.
SVS Sveriges veterinärmedicinska sällskap.
VILA Villkorad behandling – tillstånd för djurägarna att själva behandla med antibiotika.
WHO World Health Organization.
WOAH World Organisation for Animal Health, tidigare OIE.
Zoonos Smitta som går mellan djur och människor.
Bakterieceller från Staphylococcus Aureus, som kan vara en av orsakerna till juverinflammation hos mjölkkor. Den stora kapseln skyddar organis men från angrepp av kons immunologiska försvar. Bilden har tagits av en tungmetallbelagd kopia av ett frystorkat prov med 50 000 gångers förstoring i ett transmissionselektronmikroskop. Foto: Eric Erbe och Christopher Pooley, Public domain.
Miraklet som skapat ett monster – antibiotikaresistens/AMR med fokus på djur

59
Författarpresentationer
Justine Alinaitwe
Veterinär. Arbetar på Kampala Capital City Authority (KCCA), specialiserad på hälsofrämjande arbete med inriktning på förvaltning av husdjur. Har erfarenhet av arbete med frågor relaterade till klimattålig bo skapsproduktion och försiktig användning av antibiotika för att skapa hållbara och säkra livsmedelssystem.
Mattis Bergquist
Hållbarhetschef på Coop Sverige. Tidigare senior hållbarhetsrådgivare för nyckelpersoner, ledningar och styrelser. Biolog och geograf.
Åsa Domeij
Agronom och verksam som hållbarhetschef på Axfood. Har arbetat med forskningsinformation och politik på både lokal och nationell nivå och är engagerad i såväl miljö och sociala frågor som djurvälfärd. Ledamot i KSLA sedan 2019.
Lena Eliasson-Selling
Veterinär, veterinärmedicine doktor. Svensk specialist i grisens sjukdomar, Diplomate ECPHM (European College of Porcine Health and Management). Arbetat som djurhälsoveterinär på Gård & Djurhälsan (tidi gare Svenska Djurhälsovården).
Marianne Elvander
Veterinär, veterinärmedicine doktor, docent, professor emerita. Har arbetat som statsepizootolog vid Statens veterinärmedicinska anstalt (SVA) samt veterinärinspektör vid Generaldirektoratet för hälsa och livsmedelssäkerhet, Europeiska kommissionen, samt som styrelseledamot och vice ordförande i European Food Saftey Authority. Ledamot i KSLA sedan 2001.
Lena Englund
Veterinär, veterinärmedicine doktor, docent. Har arbetat vid Statens veterinärmedicinska anstalt (SVA) samt som veterinärinspektör på Jordbruksverket och som veterinärinspektör (veterinära läkemedel, djurhälsa och krisberedskap) vid Generaldirektoratet för hälsa och livsmedelssäkerhet, Europeiska kommissionen. Ledamot i KSLA sedan 2017.
Maria Lundesjö
Livsmedelsagronom och doktor i livsmedelskunskap. Arbetar med hållbarhetsfrågor inom lantbruk och livs medelsproduktion vid Axfoundation. Har tidigare arbetat som kvalitetschef och vice verkställande direktör inom slakteri och charktillverkning samt med kvalitetssäkring och hållbarhetsfrågor inom dagligvaruhan deln på ICA. Ledamot i KSLA sedan 2019.
Jenny Lundström
Veterinär, veterinärmedicine doktor. Har arbetat med Axfoundations arbete med antibiotikakriterierna från starten, redaktör för Axfoundations nyhetsbrev Antibiotikaspaning. Har varit projektledare för framtagande av ett flertal branschriktlinjer för säker livsmedelsproduktion inom primärproduktionen och har arbetat på ReAct för att inkludera antibiotikafrågor inom djurhållningen i deras ToolBox.
Kungl. Skogs- och Lantbruksakademiens TIDSKRIFT nr 5 2022
60
Ulf Magnusson
Veterinär, veterinärmedicine doktor, professor vid SLU. Har under 30 års tid arbetat interdisciplinärt med djurhållning och livsmedelsförsörjning i låginkomstländer med fokus på sjukdomar som smittar mellan djur och människor inklusive antibiotikaresistens. Jobbar med internationella organisationer som FAO, World Organisation for Animal Health, CGIAR och Global Agenda for Sustainable Livestock. Ledamot i KSLA sedan 2006.
Kristina Nordéus
Veterinär, veterinärmedicine doktor. Lantbruksråd på Sveriges ständiga representation vid EU i Bryssel. Har forskat om processen kring förbuden mot tillväxtbefrämjande antibiotika i Sverige och EU. Har arbe tat med djurskydds- och djurhälsorelaterade frågor på Landsbygdsdepartementet och sedermera Näringsdepartementet.
Majsan Pense
Inköps- och sortimentschef för kött på Coop Sverige. Lång erfarenhet inom köttbranschen med flera olika positioner. Utbildad på IHM Business School.
Susanna Sternberg Lewerin
Veterinär, veterinärmedicine doktor, docent, professor samt programchef för SLU Future One Health. Forskar och undervisar om smittsamma djursjukdomar och antibiotikaresistens samt arbetar med interdisciplinär forskning för att lösa komplexa problem inom One Health.
Sofia Toftebrant Student vid Masterprogrammet i företagsekonomi vid Örebro universitet med inriktning på Hållbart före tagande. Praktikant på Axfoundation.
Martin Wierup
Veterinär, veterinärmedicine doktor, professor emeritus. Har arbetat som statsepizootolog vid Statens ve terinärmedicinska anstalt (SVA), veterinärråd vid Livsmedelsverket (SLV) och som verkställande direktör för Svenska Djurhälsovården. Har i olika positioner arbetat med förebyggande och kontroll av djurens infektionssjukdomar med särskilt fokus på användningen av antibiotika och har anlitats som expert i olika internationella sammanhang, särskilt inom EU, WHO och WOAH/OIE. Ledamot i KSLA sedan 1998.
Annika Åhnberg
Tidigare riksdagsledamot, jordbruksminister och vice verkställande direktör med ansvar för samhällsfrågor vid DeLaval. Senior rådgivare inom området jordbruk/livsmedel i relation till hållbarhet. Hedersdoktor vid SLU. Ledamot i KSLA sedan 1999.
Miraklet som skapat ett monster – antibiotikaresistens/AMR med fokus på djur
61
Kungl. Skogs- och Lantbruksakademiens
62
nr 5 2022
TIDSKRIFT
Utgivna nummer av Kungl. Skogs- och Lantbruksakademiens TIDSKRIFT (KSLAT) (Titlar markerade med * publiceras endast elektroniskt på KSLA:s webbplats www.ksla.se. Där finns även tidigare utgåvor.)
2016
Nr 1 Kungl. Skogs- och Lantbruksakademiens verksamhetsberättelse 2015
Nr 2 Frön för framtiden – ett dialogprojekt om bioteknik i växtodlingen Nr 3 Landskapsforum 2016: Samarbetsnätverk i landskapet – möjligheter och utmaningar Nr 4 Seeds for the Future – a dialogue project concerning biotechnology in plant production Nr 5 Land och stad – nya relationer i en osäker tid
2017
Nr 1 Skogsägarens mål – en väg till ökad variation i skogen
Nr 2 Kungl. Skogs- och Lantbruksakademiens verksamhetsberättelse 2016
Nr 3 UNIK Utmaning 2016 – en casetävling om konceptet Nordisk Mat Nr 4 Landskapsforum 2017: Landskapsperspektiv i fysisk planering – helhetssyn för hållbara lösningar Nr 5 Utan pengar – inga hagar och ängar
2018
Nr 1 Menyn och tidens tecken. Måltiderna vid KSLA:s högtidssammankomster åren 2003–2018 Nr 2 Kungl. Skogs- och Lantbruksakademiens verksamhetsberättelse 2017 Nr 3 Lantbruket i diplomatins korridorer – en skrift om Sveriges lantbruksråd Nr 4 UNIK Utmaning 2017 – en casetävling om att halvera vårt matsvinn till år 2030* Nr 5 Framtidens skogsakademiker – skogsakademisk utbildning i ett tidsövergripande perspektiv Nr 6 Forests and the climate. Manage for maximum wood production or leave the forest as a carbon sink?
2019
Nr 1 KSLA Caseutmaning 2018 – ett kommunikationskoncept som ökar förståelsen för skogens olika nyttor* Nr 2 Farsoter i Sverige. Hur historien påverkar vår framtid Nr 3 Kungl. Skogs- och Lantbruksakademiens verksamhetsberättelse 2018 Nr 4 Ekosystemtjänster. Om äpplen och päron i skogen Nr 5 Landskap – ett vidsträckt begrepp. En antologi om landskap Nr 6 Svenskt jordbruk 2030 – vägen dit Nr 7 Skogliga begrepp och definitioner. Skogens alla siffror
2020
Nr 1 KSLA Caseutmaning 2019. Hur kan data berätta historien om din produkt?* Nr 2 Kungl. Skogs- och Lantbruksakademiens verksamhetsberättelse 2019 Nr 3 Galna ko-sjukan – köttmjöl och kannibalism Nr 4 Klimat och markanvändning mot 2030 Nr 5 Äganderätten och de gröna näringarna
2021
Nr 1 Kungl. Skogs- och Lantbruksakademiens verksamhetsberättelse 2020 Nr 2 Koll på kolet – kolflödet i det svenska jordbruks- och livsmedelssystemet Nr 3 Jag skulle aldrig våga flyga med en skördetröska – slutrapport från Kommittén för teknik i de gröna näringarna
2022
Nr 1 Stockholmskonferensen 50 år – att länka samman vårt gemensamma ansvar Nr 2 Svensk viltförvaltning nu och i framtiden
Nr 3 Kungl. Skogs- och Lantbruksakademiens verksamhetsberättelse 2021 Nr 4 Towards a new mindset for epidemic animal diseases
Nr 5 Miraklet som skapat ett monster – antibiotikaresistens/AMR med fokus på djur
Miraklet som skapat ett monster – antibiotikaresistens/AMR med fokus på djur 63
Antibiotikaresistens är ett globalt hot mot människors och djurs hälsa. Med fokus på resistensproblematiken tar detta nummer av KSLAT bland annat upp områden som för många är okända, inom växtodling och produktion av råvarusubstanser.

Klarar vi inte globalt att reducera an vändningen av antibiotika till en låg och ansvarsfull nivå inom såväl jordbruk som sjukvård så riskerar världen att snart stå utan möjligheter att behandla livshotande bakteriella sjukdomstillstånd. WHO bedömer att ca 10 miljoner människor kommer att dö på grund av icke behandlingsbara bakteriella infektioner år 2050. Vår förhoppning är att världen kan vända denna negativa utveckling genom brett samarbete inom sjukvård, djurhållning, och med tydligt producent-, näringsoch konsumentansvar.
Kungl. Skogs- och Lantbruksakademien
Drottninggatan 95 B Box 6806 113 86 Stockholm tel 08-54 54 77 00 www.ksla.se, akademien@ksla.se
Kungl. Skogs- och Lantbruksakademien (KSLA) är en mötesplats för den gröna sektorn. Akademien är en fri och oberoende nätverksorganisation som arbetar med frågor om jordbruk, trädgårdsbruk, livsmedel, skog och skogsprodukter, fiske, jakt och vattenbruk, miljö och naturresurser samt skogs- och lantbrukshistoria. Vi arbetar med frågor som intresserar många och berör alla!

Jenny Lundström
Jenny Lundström














